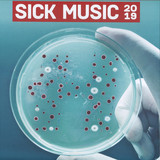
Various - Sick Music 2019

The Item is out of Stock. We will send You an Email as soon as it´s available again if you click on "in Stock Mail"
Beats News
Let's go back to the beginning of 2018 when three dubstep enthusiasts from the States started their collective alias Ternion Sound. It was a no-brainer for record label DUPLOC to immediately sign the trio for their fist ever official EP, considering the label is always up for supporting and giving opportunities to new talent. Driven by their genuine passion for the genre, Ternion Sound quickly followed up DUPLOC021 with other iconic releases on a few of the leading dubstep imprints which are Chestplate and Artikal Music UK. Fast forward to January 2019, they return to DUPLOC to release four of their hottest dubstep cuts.
The Item is out of Stock. We will send You an Email as soon as it´s available again if you click on "in Stock Mail"
Salvation is a moving soundscape from 4 beautiful lads, it's like The Sound Of Music for badasses. The flip side is the result of Cookie Monster visiting your studio to un-square it, de-nerdify it and steer it away from the 'Amazing Snare Demon and his Mixdown Massive'
Shouts to all who've been affected and upset by the passing of our good friend, Duncan Busto aka Spirit. Lets keep his name alive by playing his outstanding catalogue forever.
Q Project, Spinback, Digital & Spirit.... Amassing nearly 100 years of combined experience in the DNB scene, the four of them have done almost everything there is to do. Between them you can tick off virtually every major label from past to present - Metalheadz, Shogun Audio, Hospital, Exit, Dispatch, V Recordings, Renegade Hardware, Timeless, Reinforced, as well as their own imprints CIA, Phantom Audio, Function and Inneractive with a huge catalogue that spans dance floor anthems and underground classics alike.
The Item is out of Stock. We will send You an Email as soon as it´s available again if you click on "in Stock Mail"
- A1: Old Gang Jah - Rasta (Bernard Fevre's Black Devil Disco Dub)
- A2: Xx - Fuck The Rules Dub (Featuring - Kamal Imani Rezawrectaz)
- B1: Giuseppe Leonardi - Spiritual
- B2: Celestemariposa - Amor Forçado
- C1: Bepotel - Wetsuit
- C2: Velvet C - Word Has It
- D1: Puma & The Dolphin - I'm Just Too Shy
- D2: Anatolian Weapons - Chant One
ELSEWHERE CDXLIV is the third in soFa's carefully compiled series and the second release on the promising Brussels based Crevette Records. An exciting double LP containing 8 tracks which take the listener to a versatile journey from digital reggae over tropical balearic vibes to boogie and wave. Music which moves between styles, cultures and timezones, this time with a warmer overall flavor. A mind bending trip where 80's drum patterns bring you to exotic tribal workouts and where silky smooth synth lines lead to funky bass grooves. A spaced out affair for lovers of slow grooving music from elsewhere.
The Item is out of Stock. We will send You an Email as soon as it´s available again if you click on "in Stock Mail"
Ace ambidextrous addendum to Brandon Knocke's latest limited vinyl offering, Midnight Companion crossfades a dreamer's delight pirate mix of unreleased originals, flowing through glow-fi house, balcony bump, decadent noir, and assorted velvet rope rhythms. Both sides slip and slide with signature Body San swing, out late with nothing to lose, skipping steps up to the roof, a 36-minute 360 skyline of magic hour motion and distant city lights. Bring yourself, bring a friend.
The Item is out of Stock. We will send You an Email as soon as it´s available again if you click on "in Stock Mail"
For over twenty years, Mkl Anderson has curated a vast archive of recorded material for his cinematic ritual ambient industrial project, Drekka. He works with memory not only as a subject but also as a healing process, continually delving into this personal world of sound; examining, revisiting, and repurposing recordings in an attempt to recall a past which sings from the darkness surrounding the tenuous provinces of memory and dreams - the real ghosts of time and sound.
"No Tracks in the Snow" is a collection of tracks from the early days of Drekka's history; the third offering for Dais Records and an appendix between the second and third parts of the 'Tarwestraat' trilogy of LPs for the label.
Recorded between 1996 and 2002, the album showcases Drekka's early exploratory development across a variety of styles. And yet it is also Drekka in the present moment; culled, curated, and assembled with care. Not unlike Borges' "A Personal Anthology" - or indeed any of Drekka's own recent work - this recording can be understood as a cohesive narrative more than as a simple compilation.
As Drekka moved from its Bristol UK influenced space folk beginnings, backwards towards Anderson's earlier UK industrial tape culture foundation, his predilection for reworking pieces over time was emerging; recontextualizing narratives to bring out new truths from one's own history. This process would become a cornerstone of Anderson's work for the decades to follow.
The album begins with 'Strika' (1998), originally recorded for the lovesliescrushing side project, Vir (a "secret audio army" in which individual performers were not even aware of who the other participants were). The track features one of Anderson's earliest collaborations with Mark Trecka (of Pillars And Tongues / Dark Dark Dark), who would go on to be one of his longest standing co-conspirators.
"Christmas 1973 or 1974" (1999) is a lament for a childhood which is almost entirely forgotten and a yearning for some tangible, physical proof that this childhood existed at all. The accompanying video for the track utilizes actual home movie footage of Anderson as a very young boy, fulfilling this longing and adding heart rending weight to the song and its lyrics.
"We Who Are Not Lonely" (2000) has become one of the most beloved works in Anderson's early canon. A gauzy musing on the catharsis of upheaval, the piece was written and recorded initially in the months leading up to Anderson's relocation from Chicago to Bloomington, Indiana. It is a brooding work which shows Anderson at his most self-possessed as a songwriter and is a confluence of the earliest playing-and-singing take on Drekka and the cinematic world building soundscapes to come.
The album closes with 'Tracking shot (wide)' (2000), a brief stream-of-consciousness sound piece dedicated to Andrei Tarkovsky. The track most certainly points in the direction that Drekka would explore extensively over the two decades; the direction which has led Anderson to where he is now firmly positioned.
"No Tracks in the Snow" is an exploration of the threads of continuity which bind the various modes of Anderson's oeuvre. As he nears completion of the third album in his trilogy of LPs for Dais Records, "No Tracks in the Snow" is an introspective pause and a celebration of a life spent listening to the world around us and its sleeping potential.
The Item is out of Stock. We will send You an Email as soon as it´s available again if you click on "in Stock Mail"
Seven Dials Records enlist the expertise of Hugo alongside Fiona McMartin on vocals for their fourth release - the heavyweight UKG tinged, 'Cold Fingertips'.
There's a dark UKG flavour to the 'Vocal' mix, reminiscent of the transition from UKG into early dubstep yet softened with those silky tones. Layers of sub bass and wonky synth lines intertwine, with the skippy, 2-step rhythm providing the perfect basis for Fiona's alluring voice. Label boss Seb Zito takes it more US in style, switching to a 4x4 swung beat, chopping the vocals into a mesmerising melodic element, and adding a host of spin back samples for full garage enlightenment.
Take to the flip for a dubbed-out version of the original, allowing those killer sub synths to come to the fore whilst echoing out the vocal refrains. Closing out the EP the 'Ethereal' mix ventures deep into the realms of dubstep with monstrous undertones, glitching stutters and celestial pulsations, ready-made to cause damage in the dance.
Emotional exploration through sound can become so indulgent that it overshadows the journey. JH1.FS3 eschews mining the human condition as mediation, opting for nuanced analysis rather than vanity. Using the seeds of improvisation as their root construct, the duo work without code, vocabulary or genre. Instead, they systematically work as individuals in tandem, using disparate and varied sounds and sources to create gauzy collages of ideas, sound and visceral sense reaction.
Comprised of Frederikke Hoffmeier (Puce Mary) and Jesse Sanes (Hoax, Liebestod), JH1.FS3 delineates a more subtle 'cinema of the ear', and acold approach to reflecting on experience without leveraging tropes or familiarity.
'We try to reconcile these emotionally massive things in a way that is sincere and measured, but without being sappily diaristic or confessional,' they explain. 'A cinematic quality develops really quickly and our attempts to traffic in generalizations, unbiased observers of 'relationships' gets turned on its head. We find these sets of unique errors that feel more like Super-8 (film) home footage.
'This transference allows cracks and fissured to be filled in new ways, where error is championed—highlighted as intention rather than happenstance. Throughout Trials and Tribulations, their debut LP for Dais records, the reconnection of idea and experience conducted with surgical diligence becomes a mode to deconstruct familiarity through shade and accident.
With each exposition on Trials and Tribulations, the duo ornately exploresthe relationship between space and time by reconfiguring the tendrils and fissures that bind them. Percussive oscillations, descant vocals, and deconstructed patterns create fields that vibrate, plunge, and drone. Sequentially, each track contributes a lucid vignette to the larger account, engaging the listener to query where, when, and how they're being driven. The contrast of the lead single 'Aleppo In Headlines,' with its thrusting syncopation to the cautious beauty of 'At the Bottom of the Night' compounds and depth and disquisition of the duo's process.
The Item is out of Stock. We will send You an Email as soon as it´s available again if you click on "in Stock Mail"
Emotional exploration through sound can become so indulgent that it overshadows the journey. JH1.FS3 eschews mining the human condition as mediation, opting for nuanced analysis rather than vanity. Using the seeds of improvisation as their root construct, the duo work without code, vocabulary or genre. Instead, they systematically work as individuals in tandem, using disparate and varied sounds and sources to create gauzy collages of ideas, sound and visceral sense reaction.
Comprised of Frederikke Hoffmeier (Puce Mary) and Jesse Sanes (Hoax, Liebestod), JH1.FS3 delineates a more subtle 'cinema of the ear', and acold approach to reflecting on experience without leveraging tropes or familiarity.
'We try to reconcile these emotionally massive things in a way that is sincere and measured, but without being sappily diaristic or confessional,' they explain. 'A cinematic quality develops really quickly and our attempts to traffic in generalizations, unbiased observers of 'relationships' gets turned on its head. We find these sets of unique errors that feel more like Super-8 (film) home footage.
'This transference allows cracks and fissured to be filled in new ways, where error is championed—highlighted as intention rather than happenstance. Throughout Trials and Tribulations, their debut LP for Dais records, the reconnection of idea and experience conducted with surgical diligence becomes a mode to deconstruct familiarity through shade and accident.
With each exposition on Trials and Tribulations, the duo ornately exploresthe relationship between space and time by reconfiguring the tendrils and fissures that bind them. Percussive oscillations, descant vocals, and deconstructed patterns create fields that vibrate, plunge, and drone. Sequentially, each track contributes a lucid vignette to the larger account, engaging the listener to query where, when, and how they're being driven. The contrast of the lead single 'Aleppo In Headlines,' with its thrusting syncopation to the cautious beauty of 'At the Bottom of the Night' compounds and depth and disquisition of the duo's process.
The Item is out of Stock. We will send You an Email as soon as it´s available again if you click on "in Stock Mail"
Second Editions presents "In The Forest" by Karl Fousek.
Serving as a score for David Hartt's film of the same name about the Habitat Puerto Rico project by Moshe Safdie, In The Forest finds Fousek at his most focussed and controlled. These five pieces/chapters move with precision and intent. With subtlety and curiosity. Shrouded in ambiguity. And while Fousek works much more restrained here than on previous releases, by paying attention to every detail, he creates an intruiging work of sonic storytelling.
The Item is out of Stock. We will send You an Email as soon as it´s available again if you click on "in Stock Mail"
With "Being Water" Lali Puna refine their distinctive take on pop and electronics, pushing the boundaries towards classical songwriting. The four songs - equally affecting and catchy as self-reflected and aloof - are complemented by the airy tripiness of a remix by Dave DK (Kompakt, Pampa Records).
Although singer Valerie Trebeljahr wrote "Being Water" mostly by herself, being backed by bandmates Christian Heiß and Christoph Brandner, she rejects the idea of authorship: "Nothing comes out of myself. I'm a sampler: I write music because I listen to music. And I write lyrics because I read". Accordingly, topics and references of "Being Water" vary quite widely: "Who's That Genius" pays tribute to Virginia Woolf and Madonna - and questions why the term 'genius' is still connoted primarily with maleness. The title track refers to the famous Bruce Lee quote "Be formless, shapeless, like water" - but here it is turned upside down: It was Hito Steyerl's video work "Liquidity Inc." that got Valerie's attention, re-reading the quote as a neoliberal paradigm. In contrast, a title like "For Only Love" might sound a little naive as Valerie claims - but: "It surely won't be hate that will save us all". The lyrics were written after watching Obaidah Zytoons and Andreas Dalsgaards documentary "The War Show".
"Diversity is queen" - this goes for the music as well. While the dreamy pop of "Who's That Genius" or the catchy guitar loops of "Being Water" are in the same vein of Lali Puna's earlier albums, the free-floating piano chords and tricky rhythm patterns of "Beatx" in some ways mark new territory as Valerie explains: "I am very proud of this song because it is so fiddly. I thought that was something reserved for men".
Album Of Otherworldly Global-dance Anthems (on Soul Clap's Self Titled Imprint) And Have Been Touring Their Live Show At Venues Around The Us. Matson's Roots, While Nestled In Worldly Live Sounds, Also Firmly Grip Deeper Dance Music Styles, Though They Manage To Still Pack A Refreshingly Eclectic Energy.
His Debut Ep 'short Trips' For Brooklyn's Bastard Jazz Connects The Dots Between His Time Moving Bodies In The Club As A Dj, As Well As In His Group As A Guitarist And Producer, Though This Record Is Better Suited For A Woozy Club Floor. "roma Norte" Kicks Off The Wax With Its Soulful Cocktail Of Latin-house Styles And Hypnotic Basslines That Would Elevate The Opening Hours Of Any Club Night. Deep House Legend And Freerange Records Boss Jimpster Provides An Ethereal, Creative Remix That Delves Into Afro-house Territory. "3am To Sete" Is A Warm And Bubbly Deep House Tune That Sounds Like Something You Might Hear Late-night In A South London Nightclub—it's All Warm Bass Vibrations And Subtle Synth Explorations. Matson's Seasoned Instrumental Skills Shine On "126," Another Breezy Synth Jam With Just Enough Punch To Make You Move, Eyes Closed, Of Course. 'short Trips' Sounds Like The Work Of Someone Not Interested In Where One Scene Ends And The Other Begins, But Instead, Where They Connect.
The Item is out of Stock. We will send You an Email as soon as it´s available again if you click on "in Stock Mail"
Soundings, his debut studio album for Touch (he previously released the live album 'Floodlines' in 2016 and re-issued 'Below Sea Level' in 2017), finds Simon Scott, the composer and sound ecologist, using field recordings from various cities around the globe; modular synthesizer treatments; live strings and laptop electronics to create an album of transition and shifting time zones. The recordings were edited and composed in hotels rooms across the world as Scott was constantly on tour as the drummer for Slowdive, who successfully reformed in 2014.
Hodos, the album opener, begins with 85 mph Storm Barney recordings, ending with the fading sounds of bellbirds and cicadas recorded in Brisbane 2018. 'I took a home recording I made of Storm Barney in Cambridge, listening to it on repeat when I was flying from continent to continent. I wanted this to be the starting point of the process of musically documenting how much travelling I was doing'. This album was created from the US to Asia, South America to Europe and the Arctic Circle back to the UK via California. 'Working in hotel rooms and on flights, listening to and editing the recordings I'd made from all of these distant cities formed the basis of the album. It's the soundtrack to four years of my life in flux with constant change, jet lag, excitement and the seeming perpetual motion of travelling'.
The Item is out of Stock. We will send You an Email as soon as it´s available again if you click on "in Stock Mail"
The Noise Of Art(Blixa Bargeld,Luciano Chessa,Fred Möpert,Opening Performance Orchestra)
Works For Intonarumori (Premiere Recordings)
This album contains seven compositions, created by the Opening Performance Orchestra, Blixa Bargeld, Luciano Chessa and Fred Möpert. All the pieces relate to the theme of Futurism and employ intonarumori, instruments invented and used more than a century ago by the Italian Futurists in their noise compositions.
"In antiquity, life was nothing but silence." "Today noise reigns supreme over human sensibility."
The Art of Noises, pertained to the entire 20th century. Published in 1913, in response to Francesco Balilla Pratella's Manifesto of Futurist Musicians, Russolo's text encompassed the fundamental ideas for the new music of the modern age. Radical ideas required original compositional approaches, as well as new types of instruments - hence the Futurists opted for the intonarumori. The two quotations prompted us to give thought to creating compositions in which we would return to the early 20th century, when noises as means of musical expression emerged for the very first time. The typical instruments used by our ensemble, the Opening Performance Orchestra, are laptops, by means of which we conceive our fraction music, which can be briefly characterised by the slogan no melody no rhythm no harmony. Constructing three intonarumori, writing our own pieces for these instruments and performing works by other contemporary composers - Blixa Bargeld, Luciano Chessa and Fred Möpert, represented for us getting into close contact with the beginnings of the musical avant-garde, as well as returning to the historical roots of the music that had served as the basis of noise in art.
The Item is out of Stock. We will send You an Email as soon as it´s available again if you click on "in Stock Mail"
Obscure Kraut record inspired by the black forest, cold lakes and the south-west wind. Recorded in two days in the countryside of Valley by Daniel Meuzard aka Feater and Franco Spenzini.
Downsized production for maximum spiritual release.
* Shogun Audio are proud to present Volume 1 in our new 'Shuriken Series' . This new vinyl only range will pull together stand out tracks previously unavailable on wax onto highly collectable limited edition 4 track EP's each with it's own bespoke 'Shuriken' design and colour all on heavyweight 180g plates.
* Volume 1 features the 4 killer tunes below and will be pressed on rare 'Imperial Jade' coloured vinyl. Don't miss your chance to assemble a set of weapons any warrior would be proud of, this is the only place you will be able to get these on vinyl and the Shuriken series is strictly limited numbers, when they are gone they are gone......
The Item is out of Stock. We will send You an Email as soon as it´s available again if you click on "in Stock Mail"
Basic Rhythm arrives on Arcola following two killer albums for Type and one as East Man for Planet Mu. Up top, 'Dough Boy' rolls a tough LFO heavy dance floor number that is sure to mash heads up everywhere it is deployed, while the anthemic 'Can't You See' shifts between early AI synths and an ambient dancehall vibe that while it has its roots in early 90's jungle and hardcore, has its sight fixed firmly on the future."
Made in the Designers Republic. 12" EP house in full print outer sleeve with clear foil detailing and custom die-cut holes plus custom print inner sleeve.
Mastered and cut by Beau at Ten Eight Seven.
Limited to 500 units worldwide
- 1: Earth, Air, Fire, Water
- 2: In The Wilderness
- 3: Landscape Near Figueras
- 4: Psyche
- 5: The Nightmare
- 6: Amadeus
- 7: Red Circle
- 8: Mara
- 9: Dawn
- 10: Tears
- 11: Savage Beauty
- 12: Razor Moon
- 13: Leviathan
- 14: La Reproduction Interdite
- 15: Waves Of Violence
- 16: Churail
BurningTapes brings forth from the lake an eerie score of heavy filtering analogue synths and guitar manipulations in the score to the haunting and demonic 2019 film Black Lake by K/XI. Dripping in glassy cold reverb and abrasive Moog. Prepare for an uneasy listen.
The Item is out of Stock. We will send You an Email as soon as it´s available again if you click on "in Stock Mail"
Born Marian Himburg, Causa has been on the rise for several years now, with a tight and impressive discography on labels including Crucial Recordings, Infernal Sounds, and J:Kenzo's Artikal Music UK. Known for carefully focused cuts that marry dub sensibilities with dubstep weight, his debut for ZamZam is exactly what you'd hope: heavy 140 wares for deep dances.
'Space Dub' is an orbiting station of decaying delays and insistent bleeps that resolve into an absolutely massive riddim that causes pure murderation on the floor. Machine sounds and lasers spar over dread, lurching bass, while thick snares cut through the reverb haze to reveal the cold, starry cosmos beyond.
'Concrete Dub' works with a similarly industrial sound palette in the service of a minimalist, skanking steppers that drives hard into the heart of sound system. Disembodied voices, growling-deep horn stabs, a single piercing flute note, and a myriad of other sonic signifiers emerge and retreat, as if being pulled under by the unrelenting force of the primordial sub & kick attack. You've been warned!
Dutch duo interbellum steps up with a remarkable improvised organic electro-acoustic ambient works. One of the best Vrystaete to date.
The Item is out of Stock. We will send You an Email as soon as it´s available again if you click on "in Stock Mail"
On the next record from Main Drain Studios, Chicago artist K-rAd brings two high-tempo cuts loaded with their distinct blend of bright, nimble production.
The A-side, "174_B7B5" is a total D&B tear-out. Thundering subs carry along waves of arpeggiated synths, while whimsical samples cut the tension of the winding breakbeat flurries.
On the flip side, horns fade in and out of "154_Materials Stardust Memories ", conjuring visions of a metropolis at dusk, with jazzy interludes telling tales while lean, skittering drums & warped bass lines pepper the road along the way.
The Item is out of Stock. We will send You an Email as soon as it´s available again if you click on "in Stock Mail"
- A1: Untitled Gemütlichkeit 1
- A2: Untitled Gemütlichkeit 2
- B1: Untitled Gemütlichkeit 3
- B2: Untitled Gemütlichkeit 4
- C1: Untitled Gemütlichkeit 5
- C2: Untitled Gemütlichkeit 6
- D1: Untitled Gemütlichkeit 7
- D2: Untitled Gemütlichkeit 8
- E1: Untitled Gemütlichkeit 9
- E2: Untitled Gemütlichkeit 10
- F1: Untitled Gemütlichkeit 11
- F2: Untitled Gemütlichkeit 12
- F3: Untitled Gemütlichkeit 13
- F4: Untitled Gemütlichkeit 14
The Item is out of Stock. We will send You an Email as soon as it´s available again if you click on "in Stock Mail"
Very LIMITED album discs available now:
This is the first album Oscar Mulero has released under his own name, after two acclaimed LPs under the moniker Trolley Route. Well known for his skills as a hard-edged, raw and floor-orientated techno dj, his productions go far beyond, digging deep into the intricate landscape of intelligent techno, floating moods, reminiscent atmospheres, harmony and detail.
Grey Fades To Green is the affirmation of his maturity as a producer, using both hardware and software in the pursuit of a highly coherent and diverse album.
The concept is split into two parts: The Grey and The Green, each one with its own character. The first part is rougher and meant for the dance floor, although pays full attention to detail and complexity. The second part is quieter, has a slower pace and is best enjoyed at home.
In The Green Oscar goes deep into the intellectual side of techno music and is heavily influenced by the post rave sound emerging from the UK in the nineties: Aphex Twin, Gescom, B12, Plaid, Autechre.. but with a contemporary approach.
This part of the album brings you melodies, harmonies, endless atmospheres, and hours of studio work. Each sound has been carefully constructed, nothing is left to chance: Every stereo panning, every change to the synth's parameters has been meticulously designed for your listening pleasure; just what you want when you listen to techno on headphones. Futuristic music made with the utmost care.
'Last Regrets' shows how melancholic harmonies can be a perfect match for abstract beats and a dub-step reminiscence. A fine piece of sci-fi techno.
'Grey Fades To Green' makes a clean break by offering us an industrial drum'n' bass piece with a techno approach that mutates as the minutes tick by. A dub-step melodic track. Futuristic breakbeat for the decades to come.
The final track of The Green, 'Silent Air', picks up the homage to the intelligent techno sound of the beginning and returns to random grooves, crunchy samples, impossible hi-hats and massive synthesizer and step sequencer routines. A perfect ending to this sound journey from the heart of the dance floor to the core of your mind.
A mature work that confirms Oscar Mulero as one of the most qualified studio animals on the techno landscape.
Hollow Earth is the new album from Pye Corner Audio aka Martin Jenkins, his third for Ghost Box. It's conceived as a sequel to 2016's Stasis. Where Stasis played with notions of outward cosmic exploration and the idea of suspended animation and sleep, Hollow Earth takes subterranean exploration and submerged psychologies as its theme.
It draws on Berlin school synth improvisations, New Age reveries and the ghosts of 90s house euphoria to summon up images of vast, awe inspiring spaces and claustrophobic chambers. It sustains an atmosphere of wonder and adventure throughout, and like its companion piece, Stasis, it works equally as a soundtrack to physical as well as mental exploration.
Pye Corner Audio specialise in majestic, cinematic electronica that evokes sci-fi soundtracks, dystopian futures and the sound of haunted dance floors. The discography to date includes eight full length albums and many more singles and EPs across several labels. There are also remixes for John Foxx, Mogwai, Mark Lanegan, Stealing Sheep, Knightstown, Not Waving and most recently Dolphin Midwives.
Pye Corner's Martin Jenkins (aka The Head Technician) is a veteran live performer, and has played shows and festivals all over Europe, Canada and the USA. Most notably he has supported Mogwai on several tour dates, played the Mutek festival in Montreal, the Mugako Festival in Spain and Barcelona's Primavera Club.
Pye Corner Audio pieces appear in the soundtrack to Adam Curtis's 2016 film HyperNormalisation and the 2018 Shudder TV series, Deadwax. More TV soundtrack appearances are due to appear in 2019.
The Item is out of Stock. We will send You an Email as soon as it´s available again if you click on "in Stock Mail"
- A1: Begleitung Für Tuba
- A2: Inversion
- A3: Proto
- A4: Metazoon
- A5: Momentaufnahme
- A6: 2 Ton
- A7: Speichen
- A8: Modes
- A9: Expansion (Version)
- A10: Synchronton 2
- B1: Atmosphäre 1
- B2: Punkte
- B3: Expansion
- B4: Für Ulrich
- B5: Pulsation
- B6: Testlauf
- B7: Soloresonanzen
- B8: Photosphäre
- B9: Rhythmus 80
2018 Vinyl Remaster. Von Jan Jelinek kompilierte Werkschau der legendären musizierenden Pharmazeutin.
Die Geschichte der Entdeckung dieser Aufnahmen klingt abenteuerlich. Es soll Ursula Bogners Sohn
Sebastian gewesen sein, der auf einem Flug seinem Sitznachbarn, dem Elektronikmusiker Jan Jelinek, vom
ungewöhnlichen Hobby seiner Mutter berichtete. Ursula Bogner, 1946 in Dortmund geboren, dann in Berlin
als Pharmazeutin bei einem großen Pharmaunternehmen beschäftigt, hatte ein Faible für elektronische Musik
und die Musique concrète. Ab Ende der 60er-Jahre nahm sie eigene Stücke auf, die sie jedoch nie
veröffentlichte. Bogner war stark von den pseudowissenschaftlichen Energietheorien Wilhelm Reichs
("Orgon") beeinflusst und bastelte sich einen eigenen Orgon-Akkumulator. 1994 verstarb Ursula Bogner.
2008 veröffentlichte Jan Jelinek unter dem Titel "Recordings 1969-1988" eine erste Werkschau Bogners, die
jetzt als remasterte Vinyl Version wieder veröffentlicht wird.
Second release from Twin Womb after last year's incredible "Aeons Revolve" 12". 21 tracks, hand-numbered (very) limited edition cassette. Comes with sticker.
The Item is out of Stock. We will send You an Email as soon as it´s available again if you click on "in Stock Mail"
The third release for Planet Euphorique comes from none other than D. Tiffany herself, delivering four tracks of delicate yet driving, emotional anthems for prime-time dance floor bliss. 'Feel U' shows spacial finesse and rhythmic maturity, rumbling robotic basslines elevate the undeniable euphoria supplied by glowing pads and fleeting vocal earworms. Whilst the EP is diverse in mood and colour, that undeniable D. Tiff steeze is laced through from start to finish, resulting in a crucial record suitable for the club, after party or the next morning.
The Item is out of Stock. We will send You an Email as soon as it´s available again if you click on "in Stock Mail"
After a flury of Wilson Limited Releases, Wilson Records Honcho, Fabio Monesi storms back on his beloved project with 'Say Wot!' EP! While the latest releases have been inspired by the infectious ferocity of earlier Chicago house records, 'Say Wot!' splits off in another direction entirely. Working in elements of the classic sounds that msde the french-house anthems dominate the air waves for so long, its shaping up to be a real head-spinner in the club. 'Asap900', the B-side of the record, brings us back to the golden era of the wareshouse-raves. A straight up, no holds barred kick drum-driven rythm-machine.
Mastered at Reel Mastering, London
The Item is out of Stock. We will send You an Email as soon as it´s available again if you click on "in Stock Mail"
Teresa Winter's LP debut Untitled Death is a hallucinogenic wormhole of sensuously ambiguous pop and electronic experiments primed for the after-after party and altered states of reception.
Realised thru a mesh of strategies from live, lo-fi tape recordings of synths, samplers and vocals to nascent experiments with algorithmic software, Untitled Death is both a divine revelation of new aspects to Teresa's sound and an expansion of The Death of Rave's as-yet-unidentified aesthetic.
Teresa's zoomed photos of magic mushrooms spattered in popping fluorescent oils which adorn the cover of Untitled Death hint at a more personalised insight and psychoactivity, a proper, lush trippiness. Just like the putative psilocybic experience, Untitled Death naturally comes on in waves of synaesthically-heightened sensuality, from strangely libidinous stirrings to utter, eat-your-heart-out euphoria with a spectrum of hard-to-explain and unexpected sensations between.
We can hardly recall a more seductive album opener than Oh, which blossoms from plaintive drum machine and chiming pads to a half- or mis-heard beckon I really like it / when you let yourself go / I really want you inside me / I want to make you my own', before curdling into bittersweet partials and deliquescent hooks as earworming as anything from AFX's SAW 85-92 classic.
It's devastating in its simplicity and almost blush-worthy in effect, and is soon enough lopped curtly into the soundtrack-like enchantment of Untitled Death, which could almost be a cue from some '60 Polish or Czech art-house film, serving to neatly set up the prickling, windswept scene of romantic introspection and dereliction in Pain Of Outside - perhaps Teresa's most accomplished and affective pop turn to date, think Grouper awkwardly blissing out at 9am in the corner of a successful sesh/campsite/free party.
From that perfectly damaged side closer, the B-side opens to a different sort of spine-freezing beauty and sense of abandonment with plangent, dissonant harmonics describing rugged Yorkshire wolds and coast as much as a radiant lightshow on the back of flickering eyelids.
The Item is out of Stock. We will send You an Email as soon as it´s available again if you click on "in Stock Mail"
The latest episode on Piezo's no nonsense, hand stamped and heart warmed Ansia label has arrived! ANSIA003 is the follow up to his early 2018 'Parrots EP' and for this release the Milanese producer has enlisted 3 other disparate yet like minded artists to let loose on this monster 4 tracker. StabUdown Productions (James Donadio aka Prostitutes) kicks it off with the opener 'FyeRRR!' A deadly burst of blown out ragga replete with an arsenal of kicks and vocal cut up shrapnel. Next up label head Piezo drops 'OiOiOi', a masterwork of electro gated basslines, jungle breaks and absurd delay feedbacks. A perfect continuation of the surrealistic/abstract path started by tunes like 'All My Money' on 'Parrots EP'. Fresh off his Lobster Theremin's album, Kreggo/G-23 (Super Rhythm Trax, Secret Rave, Art-Aud) delivers 'Ligeti': a flat out mover with it's skittering percussion and deep haunted stabs hovering around the supernatural subs. It all finishes up with Bristol's Facta, whose releases on Idle Hands, Livity Sound and his own excellent Wisdom Teeth really needs little introduction. 'Not Now' is an elastic, low gravity heavy hitter that snakes through bass bins and before you know it, you're completely wrapped.
Born in 1974, Aymeric de Tapol is a composer living in Brussels. He writes scores for contemporary dance projects, cinema, radio, and aims to tell stories through his audio creations and recordings. His music has been played on The Word Radio, Radio Panik, and NTS in shows including The Hot Selection, featured first on 26 July 2015. Songs played include 'La ronde des beaux yeux', 'J'ai dansé avec elle' and 'Les attractions'. He is a prolific producer of audio across styles and mediums.
The double 7-inch, BOMBINA, is Aymeric de Tapol's third release for Ångstrom Records. Each track evokes a different compositional mood, although the entire release can nicely fit into the traditions of drone & continuous music.
BENJAMIN FINGER, JAMES PLOTKIN and MIA ZABELKA craft a mesmerizing sonic world that buzzes and drones, glitches and slithers, eventually careening into unexplored musical territory.
"Pleasure-Voltage" was born in the mind (and studio) of BENJAMIN FINGER - a composer, electronic music producer, DJ, photographer and film-maker based in Oslo / Norway who in recent years has become quite a prolific artist, expanding his stylistic palette from piano miniatures and off-kilter pop experiments to lysergic, dream-like sound collages spiced with gentle warmth and sublime melody. These ingredients are also characteristic on this latest work where FINGER set the musical frame before passing it on to his inspired collaborators: MIA ZABELKA who for decades now has been involved in countless projects, be it as musician (violin / electronics), curator or founder of the international sound art centre klang.haus and who has worked with a.o. JOHN ZORN, FRED FRITH, ELECTRIC INDIGO, ROBIN RIMBAUD (SCANNER), DÄLEK or PHIL MINTON. And last but not least there's JAMES PLOTKIN who entered the scene with his first band OLD LADY DRIVERS (or OLD) on EARACHE in 1987 and later was a member of KHANATE (with a.o. STEPHEN O'MALLEY) while also exploring the areas of dark ambient and electronics by working with or remixing SCORN / MICK HARRIS, K.K: NULL and many more.
On "Pleasure-Voltage" which had its live-premiere at the REWIRE festival 2018, the trio craftsa mesmerizing sonic world that buzzes and drones, glitches and slithers, eventually careening into unexplored musical territory somewhere between ambient / drone / psychedelia.
Duckett returns to Wisdom Teeth with another otherworldly four-tracker of melodic, trippin' house-n-techno. While recent outings on Berceuse Heroique and Solar Phenomena have showcased the more abstract edges of his sound, Corde Raide Vers Nulle Part comprises a collection of the Welsh producer's most melodious work to date. Throughout, the tracks are driven by snaking FM basslines, shimmering video game synths and tonal drums, creating a record that will appeal equally to fans of golden era Night Slugs, bleeping minimal techno, and the compositional electronica of labels like RVNG International and Latency.
5x12"[59,62 €]
Critical Music reaches its 100th release in its 15th year, celebrating with the landmark album Fifteen Years Of Underground Sonics. Spanning the broad spectrum of drum & bass that the Critical sound represents, the exceptional 15 album is as bold as it is beautiful and looks to serve the test of time in the D&B history books.
--
Over the past 15 years the label I started as a hobby, as a way to involve myself in drum and bass, has taken over my life. I m so lucky to have worked with such incredible artists, have them realise their creativity, and travelled all over the world spreading the sound I love.
I deliberated for a long time over what type of record we should put together to celebrate reaching both our 15th birthday and 100th release. I like to think of us as a label that looks forward, that focuses on what the future holds and on how to make statements without sacrificing our core ideals, to release exciting music centred around the 170bpm tempo. So with this in mind I wanted the LP to be about where the label is now and where it s going, a snapshot of the music that represents the Critical sound by core label acts and some choice friends.
This album is an insight into Critical Music in 2017 and a thank you to all who have been involved in any way over the past 15 years.
--
Kasra Critical
The Item is out of Stock. We will send You an Email as soon as it´s available again if you click on "in Stock Mail"
5x12"[59,62 €]
Critical Music reaches its 100th release in its 15th year, celebrating with the landmark album Fifteen Years Of Underground Sonics. Spanning the broad spectrum of drum & bass that the Critical sound represents, the exceptional 15 album is as bold as it is beautiful and looks to serve the test of time in the D&B history books.
--
Over the past 15 years the label I started as a hobby, as a way to involve myself in drum and bass, has taken over my life. I m so lucky to have worked with such incredible artists, have them realise their creativity, and travelled all over the world spreading the sound I love.
I deliberated for a long time over what type of record we should put together to celebrate reaching both our 15th birthday and 100th release. I like to think of us as a label that looks forward, that focuses on what the future holds and on how to make statements without sacrificing our core ideals, to release exciting music centred around the 170bpm tempo. So with this in mind I wanted the LP to be about where the label is now and where it s going, a snapshot of the music that represents the Critical sound by core label acts and some choice friends.
This album is an insight into Critical Music in 2017 and a thank you to all who have been involved in any way over the past 15 years.
--
Kasra Critical
The Item is out of Stock. We will send You an Email as soon as it´s available again if you click on "in Stock Mail"
5x12"[59,62 €]
Critical Music reaches its 100th release in its 15th year, celebrating with the landmark album Fifteen Years Of Underground Sonics. Spanning the broad spectrum of drum & bass that the Critical sound represents, the exceptional 15 album is as bold as it is beautiful and looks to serve the test of time in the D&B history books.
--
Over the past 15 years the label I started as a hobby, as a way to involve myself in drum and bass, has taken over my life. I m so lucky to have worked with such incredible artists, have them realise their creativity, and travelled all over the world spreading the sound I love.
I deliberated for a long time over what type of record we should put together to celebrate reaching both our 15th birthday and 100th release. I like to think of us as a label that looks forward, that focuses on what the future holds and on how to make statements without sacrificing our core ideals, to release exciting music centred around the 170bpm tempo. So with this in mind I wanted the LP to be about where the label is now and where it s going, a snapshot of the music that represents the Critical sound by core label acts and some choice friends.
This album is an insight into Critical Music in 2017 and a thank you to all who have been involved in any way over the past 15 years.
--
Kasra Critical
The Item is out of Stock. We will send You an Email as soon as it´s available again if you click on "in Stock Mail"
The Item is out of Stock. We will send You an Email as soon as it´s available again if you click on "in Stock Mail"
Khalab's 'Album of The Year' has been re-worked!
Ahead of a full remix LP (Summer 2019) On the Corner have opened the vault on 2019 hitters.
This 12' scorches the terrain built by 'Black Noise 2084'.
Hieroglyphic Being dominates the dancefloor with his 10 min sweater.
Afrikan Sciences launch off from Khalab's afrocentric soundscapes into a futuristic cosmos.
Blood, Wine or Honey strip it back, break it down and leave bassments trembling with the
weighty jungle blows.
After a stellar year for Khalab and On the Corner these three remixes bring knock-out blows
for 2019 dancefloors.
Hieroglyphic Being's 10 min sledgehammer shakes the floor as the mythical producer runs a
profound groove with three 808s pummelling the spine of Khalab's track.
On the B side, Afrikan Sciences uses the Afrocentric theme of the original to strip it back and
propel it into the cosmos.
Khalab's 'Black Noise 2084' has already racked up 'Album of the Year' status and we're giving
you a first glimpse of this earth scorching, dance destroyer that will prepare an onslaught for
2019.
'Although discrete, the career of saxophonist Philippe Maté includes nonetheless several indispensable albums: be it with the Acting Trio, Jean Guérin (Tacet) or Jef Gilson (Workshop), his collaborations in a big band or quartet with Lawrence "Butch" Morris, his presence in the Saxophone Quartetand also on the brilliant L'Enfant assassin des mouches by Jean-Claude Vannier.
As for the man in the background, Daniel Vallancien, a sound engineer rarely featuring on the sleeves, the collection Actuel on the BYG label owes much to him (he is at the controls behind Anthony Braxton, Don Cherry, Sonny Sharrock or Steve Lacy), the same goes for Saravah for who he notably recorded Areski,Brigitte Fontaine, Maurice Lemaître or the Cohelmec Ensemble: not bad for starters! What is more, Daniel Vallancien is one of a prestigious group of French recording engineers with open ears and often themselves musicians, even if only occasionally for some, including Bruno Menny, Daniel Deshays or Jean-Marc Foussat, who have all recorded remarkable albums as leaders. Behind this collaboration was the idea of creating music which was free, direct and spontaneous, while having also a minimum of advance planning. Music, according to the brief liner notes, desires to "remove itself from long and patient laboratory experiments ". So there can be found here none of the sophisticated tools associated with electroacoustic research, but mainly a recording mixer console, which, in the hands of Daniel Vallancien acts directly on the original instrumental sound in real time, modifying and multiplying it while respecting the natural flow.
Be it Paul Méfano, Betsy Jolas, Gérard Grisey or Jacques Lejeune, many contemporary composers working in France have, at one time or another, included the saxophone in their work. Michel Redolfi, for example, with the GRIM and then the CIRM , experimented with saxophonist André Jaume on a convincing recording (Hardscore). Nothing, however, can compare to the singularity of the dialogue between Philippe Maté and Daniel Vallancien, which they themselves describe as being "serious, sarcastic or humorous", with, here and there, "disturbing sounds". Words, however, even those used by the protagonists themselves, are insufficient to describe such a sonic object, difficult to identify and, it has to be said, extraordinary.'
The Item is out of Stock. We will send You an Email as soon as it´s available again if you click on "in Stock Mail"
3 Rough and ready discotheque weapons, thought to be long lost, but now back on the streets for your DJ bag. Super limited vinyl only pressing. Early support from: Ben UFO, Midland, Gilb'R, DJ Nature, The Maghreban, Joe, Erol Alkan & more.
From a discarded CDR, rediscovered in a dark corner in a sun kissed flea market in Versailles we bring you some rare and unheard personal edits from the archives of the city's Pierre Yves Marie. A name not familiar to many, Pierre was a locally known DJ and switched-on music lover whose interests in Disco, Italo, HI-NRG and early house sounds led him to visit the USA - particularly the midwest - numerous times throughout the late 80's and early 90's. It was here, inspired by the DJ's he heard firsthand in Chicago, Detroit and other places he visited that he became inspired to create his own versions and mixes of tracks to play at his small Disco parties at the city's "Les Caves Du Roi", an intimate club space that allowed Pierre to create his own atmosphere where he attracted a hedonistic, stylish and very mixed crowd to hear him play. These edits were rediscovered a few years back, languishing in a shoebox at said flea-market, dumped after Pierre's struggles with the 'party life' in the late 1990's and he was eventually tracked down via some solid detective work and local knowledge. He has, after much discussion, very kindly allowed a limited amount of these unique DJ tools to be pressed onto wax. Being a keen follower of technology, he had originally transferred his reels and tape edits onto CDR's in the early 1990's, which lends a lo-fi and raw vibe to these edits. We feel this surely adds charm and beauty to these roughly hewn personal mixes and we are lucky to be able to share in this small piece of history.
The Item is out of Stock. We will send You an Email as soon as it´s available again if you click on "in Stock Mail"
Introducing T-Flex London based artist and visual designer. Discovered when Datassette dropped one of his WIPs at the null+void Recordings launch party, there was an instant hook on his playful and intelligent sound. We're super honoured to be able to give his productions their first official home and cut to vinyl.
It's a bold and exciting debut - showing of a flair for pairing deep sub-bass with quirky off kilter rhythms and grooves. This from someone who's embedded himself in London's musical world - avidly following what's going on and interpreting it with a fresh new take.
Artwork by T-Flex. Mastered and cut by Keith Tenniswood at Curve Pusher.
The Item is out of Stock. We will send You an Email as soon as it´s available again if you click on "in Stock Mail"
The Item is out of Stock. We will send You an Email as soon as it´s available again if you click on "in Stock Mail"
'Transcendence' serves to illuminate a burning playing field of ideas. Converging acoustic and high register digital manipulation, poetry and transformative soundscapes to form a haunting veil over a dynamic sphere of sound and words. Opening track 'Petrol' an intense poem that lists twenty-seven violent attacks in and around London, "twenty-seven survives but now feels out of place with the seismic shift - originally featured on 'Euthanasia Party / Twenty Seven'.'Jhonn' a homage to the great Jhonn Balance from Coil slowly rises from feedback with weightless melodies. 'War Text' automatic percussion turns to delirium over organs & soft-spoken lyrics "Lots of things trembling, the vase on the counter, the fake flowers".'Deity' delicate hymns transform into mechanical turmoil. 'Durchreise' static showers veil techno intervals through a cold soundscape. 'New World' Ascending arps & guitar riffs meshed with delicate choirs. Closing the LP is 'Gar' a synthetic organism that blurs the lines of A.I.
The Item is out of Stock. We will send You an Email as soon as it´s available again if you click on "in Stock Mail"
The Item is out of Stock. We will send You an Email as soon as it´s available again if you click on "in Stock Mail"
5x12"[59,62 €]
Critical Music reaches its 100th release in its 15th year, celebrating with the landmark album Fifteen Years Of Underground Sonics. Spanning the broad spectrum of drum & bass that the Critical sound represents, the exceptional 15 album is as bold as it is beautiful and looks to serve the test of time in the D&B history books.
--
Over the past 15 years the label I started as a hobby, as a way to involve myself in drum and bass, has taken over my life. I m so lucky to have worked with such incredible artists, have them realise their creativity, and travelled all over the world spreading the sound I love.
I deliberated for a long time over what type of record we should put together to celebrate reaching both our 15th birthday and 100th release. I like to think of us as a label that looks forward, that focuses on what the future holds and on how to make statements without sacrificing our core ideals, to release exciting music centred around the 170bpm tempo. So with this in mind I wanted the LP to be about where the label is now and where it s going, a snapshot of the music that represents the Critical sound by core label acts and some choice friends.
This album is an insight into Critical Music in 2017 and a thank you to all who have been involved in any way over the past 15 years.
--
Kasra Critical
The Item is out of Stock. We will send You an Email as soon as it´s available again if you click on "in Stock Mail"
The Item is out of Stock. We will send You an Email as soon as it´s available again if you click on "in Stock Mail"
Ay, caramba! Tropical dandy Rick Shiver's hot-yet-cool solo debut. The A-side has a sweet cha-cha de amor, take the chill of your chili and blush several shades of picante. The B-side adds some mariachi vibes for a 'stripped to the bone' dub. Blame it on the chili. Spicy!
The Item is out of Stock. We will send You an Email as soon as it´s available again if you click on "in Stock Mail"
Techno Thriller joins the Unknown Precept fam with a brand new mini-album. The first following the release of their eponymous full-length album a couple of months ago. Based in Brussels, although now relocating themselves in Marseille, France, the four-handed formation has steadily been crafting cybernated Gothic music over the past years. Recorded a few months back while drawing its inspiration from dark dungeons and occult folklore, not without evocative titles, Enfant de Sodome feels as muscular and thrilling as their live performances usually imply. Compelling murky synthpunk and industrial machinery colliding in fervor and howls. Free falling tumultuous bass lines lacerated by ominous muffled groans. Bone-bending primitive techno music catapulted over the walls in the most urgent fashion. At the end, it very much feels like trying to dance on some sort of cryptic electronic body music in a heavy chain-mail.
One of the first techno-pop songs made in USSR. Written and produced in his Kiev home studio in 1985 by Ukrainian composer Vadim Lashuk. Source audio from master tapes discovered in the attic were kindly provided for this release by the author's family. Limited to 300 copies vinyl edition.
FOKUZ066.3: In this last part of the 15 Year vinyl series we find drum & bass all star Lynx remixing 'Midnight Runaway' by Intelligent Manners & Enei. Fresh sounds all over, we're very happy to have him as a part of this project. On the flip Amaning and Dramatic deliver the goodness with Moods! Superb rolling sounds that are perfect for sunny, chilled days. Better get both tunes for the full effect!
---
LUV001VN: LuvDisaster is a Drum and Bass Music Record Label with brazilian and international artists around the world. After the big success of their digital releases they now present a nice piece of vinyl for the fans.
Liquid Drum and Bass at its best here in true summer style. And the flip holds a classy LYNX remix.
---
AMBRA12003: Ambra Recordings gears up for their third vinyl release this time featuring drum & bass heavyweights Lynx and Random Movement on remix duties.
Fresh of his debut album on Hospital, the the A side sees 'Lynx' bring the ruckus flipping 'Moon Love', an already strong original by Ambra headhoncho Emery together with Garo and Umiko. Clever, distinguished sound design and outstanding vibes coming from the man known for his malificent, dark-toned melodies and progressions. The playfull and clever drum programming with little edits and percussion is underlined by an undulating bassline that provides an intricate look at his unique style of production.
The Item is out of Stock. We will send You an Email as soon as it´s available again if you click on "in Stock Mail"
Critical Music reaches its 100th release in its 15th year, celebrating with the landmark album Fifteen Years Of Underground Sonics. Spanning the broad spectrum of drum & bass that the Critical sound represents, the exceptional 15 album is as bold as it is beautiful and looks to serve the test of time in the D&B history books.
--
Over the past 15 years the label I started as a hobby, as a way to involve myself in drum and bass, has taken over my life. I m so lucky to have worked with such incredible artists, have them realise their creativity, and travelled all over the world spreading the sound I love.
I deliberated for a long time over what type of record we should put together to celebrate reaching both our 15th birthday and 100th release. I like to think of us as a label that looks forward, that focuses on what the future holds and on how to make statements without sacrificing our core ideals, to release exciting music centred around the 170bpm tempo. So with this in mind I wanted the LP to be about where the label is now and where it s going, a snapshot of the music that represents the Critical sound by core label acts and some choice friends.
This album is an insight into Critical Music in 2017 and a thank you to all who have been involved in any way over the past 15 years.
--
Kasra Critical
The Item is out of Stock. We will send You an Email as soon as it´s available again if you click on "in Stock Mail"
Mantra Music' is the sister label of 'Deeper Vibrations', a Youtube channel devoted to promoting the deeper sounds of dubstep. Following the success of this promotional platform, the decision was made to start a new label which focused on contemporary bass music with a classical twist. So far, their debut offering has been supported by Sub.fm DJ's BunZer0 and Syte, and Author's DJ Ruckspin, who are all well known for pushing forward thinking bass music within the underground scene. Guy Chambers, aka Quantum Soul, has caused quite a stir over the past few years with his unique take on the dubstep sound. His ability to combine emotive musicality with powerful sound system presence has seen him release on many highly regarded labels including Innamind Records, Tribe 12, Mindstep Music, Tuba NYC, NoMad and the inimitable Ranking Records - to name but a few. His signature deep, rolling percussive style and heavy sub bass have been quaking dance floors since 2007, but it's his huge reworking of 'Strong Root' by UK group Lamb in 2013, that earned him the admiration of both soulful bass music listeners, and dance floor skankers alike. Since then his music has received support from the Rinse dons DJ Youngsta, J:Kenzo and Vivek as well as international support from the likes of Joe Nice, True Nature and Shiba. Katya Gabeli is a classically trained violinist, singer, producer and DJ from the Netherlands, with a keen interest in combining her musical passions wherever possible. Performing both live violin performances during DJ sets and conducting studio work with artists such as BunZer0 and Congi, has seen her work released on dubstep labels Mindstep Music and Chord Marauders, as well as leaving her mark on the tech house scene with labels Acker Records, Doppelgaenger, Budenzauber and Tretmuehle. 'Emergence' comes from both Quantum Soul & Katya Gabeli, with the idea of fusing classic western music with a contemporary approach. The track was created through a lengthy exchange of ideas and the finished article is spine-tinglingly sublime. Opening up with a sparse violin solo, the track builds tension from the outset towards a chorus of strings; time is marked by thunderous percussion hits offering a suggestion of what lies ahead. The serene strings and rolling bass are the main focal points, beautifully enveloping the complex percussion and complimented by soft vocal atmospherics, which hold the listener in suspense and anticipation throughout. The breakdown is expertly engineered so as to seemingly evaporate into nothing, allowing the next round of tension/release to begin again with further compositional details continuing until the end. 'Emergence' is a totally immersive experience on headphones and demands full attention through a sound system; it is unlike any strictly 'classical' or 'dubstep' music you have ever heard before, being a perfect synergy of both art forms. 'Nemawashi' is a solo effort from Quantum Soul, with the intention of bringing the percussive drama from classical music to the sound system. Opening up with a rhythmic intro built around low-end percussion and a dubwise hi-hat, the pace quickens as a steady marching kick reinforces the serious intent of the groove. The sounds of traditional Japanese instruments hang around the booming percussion giving a subtle air of mystery before the track erupts into an onslaught of brutal rhythm and bass. The half-time rhythmic skank, skilful blending of booming percussion and sub bass, combined with recurring Japanese motifs draped in echo and reverb all coalesce to ensure the energy of this track marches on powerfully without getting repetitive. 'Nemawashi' is the heavy weight, powerful Yang to the beautifully delicate Yin of 'Emergence' making for a balanced EP, which is an absolute must for any dubstep or bass music 'head', whether the intention is to play it out, or listen on headphones.
The Item is out of Stock. We will send You an Email as soon as it´s available again if you click on "in Stock Mail"
Les Disques du Crepuscule presents Signals Into Space, a brand new studio album by acclaimed electronic duo Ultramarine. SIS is their seventh album, having debuted on Crepuscule back in 1990.
The new long player was conceived by Ian Cooper and Paul Hammond over a three year period and features four songs co-written with North American musician Anna Domino, a firm favourite of the group since her leftfield pop releases on Crepuscule and Factory in the 1980s. 'For this project we wanted to do something more ambitious and perhaps more accessible than our last album in 2013,' explains Paul. 'We were keen to start collaborating with other musicians again, as well as develop our method of performance-based writing and recording, which is partly improvised.'
Signals Into Space also features contributions from saxophonist Iain Ballamy (ECM, Food, Loose Tubes) and percussionist & vibraphone player Ric Elsworth. It was recorded and mixed in London with Andy Ramsay (Stereolab) and mastered by Noel Summerville.
'To some extent Signals Into Space is an escapist record,' reveals Ian. 'Our rehearsal space is a small windowless room on an industrial estate in Essex. Possibly as a result we ended up with a collection of visually suggestive tracks, conjuring mental images of cities, deserts and tropical islands, which gradually came into focus as Anna's lyrical ideas developed. So while the music might have been conceived in a closed space it's imbued with a positive spirit - looking outwards, seeking contact.'
Cover art by Studio Heretic. Available on CD, digital and vinyl LP (vinyl format includes a free digital copy on MP3).
The Item is out of Stock. We will send You an Email as soon as it´s available again if you click on "in Stock Mail"
welcome to the sounds of 'day by day', a wex sub label. four tracks mixing electro, techno, trance, house and ambient. adam pits, lisene, anderson and nella are responsible for the sounds. this will be a limited pressing to celebrate the first release, so be sure to secure your copy!
The Item is out of Stock. We will send You an Email as soon as it´s available again if you click on "in Stock Mail"
LP 1 ist das Debütalbum von AIRCHINA, dem jüngstes Projekt von Nikolai Szymanski - Komponist, Sänger, Elektroniker und Umschlagkünstler von Stabil Elite aus Düsseldorf. Pluckernd analoge Rhythmik, subtraktive Synthese und Softwaresynths. Melodien schichten sich licht in asiatisch anmutendem Gewand. Aber nicht so einfach: ein fremder Blick. Eine Idee von Japan. 1983, 84, 85. Getrennt durch Raum und Zeit. Von hier aus gesehen, Düsseldorf. Signale, wie sie Pyrolator empfing, Tokyo, wie es Hosono Haruomi und Ryuichi Sakamoto beschrieben. Ambient-instrumentale Eleganz, Kammerstücke, Miniaturen, Popschönheit - wer Namen braucht: The Orb, Ultramarine oder auch Oneohtrix Point Never im Sinne.
LP 1 is the debut album of AIRCHINA, the latest project by Nikolai Szymanski - composer, singer, electronic musician and cover designer of german neo-kraut band Stabil Elite from Dusseldorf. Plucking analog rhythms, subtractive synthesis and software synths. Melodies layer light in asian-sounding scapes. But not so easy: A strange view. An idea of Japan. 1983, 84, 85. Separated by space and time. Seen from here, Dusseldorf. Signals as Pyrolator received them, Tokyo, as described by Hosono Haruomi and Ryuichi Sakamoto. Ambient-instrumental elegance, chamber pieces, miniatures, pop beauty - who needs names: The Orb, Ultramarine or Oneohtrix Point Never.
The Item is out of Stock. We will send You an Email as soon as it´s available again if you click on "in Stock Mail"
Following the 'Screaming Ghosts' collection highlighting the music of C Cat Trance, Emotional Rescue and Malka Tuti return with the first of two EPs where the band's music is given over to a selection of artists, friends and collaborators for reinterpretation, re-editing, replaying and remixing to provide a modern outlook on the bands mixture of East meets West musicology.
Very much the vision of Malka Tuti and close to their ground-breaking releases of the last two years, the genius is out of the bottle with a who's who representing both labels. First, Autarkic go supergroup in enlisting Tel Aviv's White Screen for a cover of Screaming (To Be With You). Totally replayed, this is the perfect opening, with wide-screen production, updated arrangement and decimal delivering vocals setting the standard.
Following comes an effusive, simple and on-point remix of Dalbouka by the inspiring ledge that is JD Twitch. Platitudes aside - enough has been said by others - but the fact Twitch is as enthusiastic and driven as ever is testament enough. The simplicity and genius of his rework, where 909 is added alongside fx to speaker shaking effect, shows that less can be much more.
In Sneaker (DJ) we have a name moving steadily from the (cult) periphery to become one to consistently check and respect. Following EPs for Rat Life and Bahnsteig 23, the singularity of his reversion is audacious and entrancing. Brevity, purity and ultimately intensity of percussion, horns, bell and guitar. Enter.
To end volume 1 comes Die Orangen. Kris Baha and Dreems' bromance of Aussie label (red) heads, united in post-industrial explorations. With a deep, expansive album incoming on Malka Tuti, their brooding, rattling, ghostly mix is one for late night thinkers, that steps up to encapsulate an EP that successfully marries old and new, bringing C Cat Trance's music present.
- A1: Doki Doki Literature Club!
- A2: Ohayou Sayori!
- A3: Dreams Of Love And Literature
- A4: Okay, Everyone!
- A5: Play With Me
- A6: Poem Panic!
- A7: Daijoubu!
- A8: My Feelings
- A9: My Confession
- A10: Sayo-Nara
- A11: Just Monika
- A12: I Still Love You
- A13: Your Reality
- A14: Poems Are Forever
- A15: Doki Doki
- B1: Trailer!
- B2: Okay, Everyone! (Sayori)
- B3: Okay, Everyone! (Natsuki)
- B4: Okay, Everyone! (Yuri)
- B5: Okay, Everyone! (Monika)
- B6: Dreams Of Love And Literature (Early Sketch)
- B7: Daijoubu! (Early Sketch)
- B8: Ohayou Sayori! (2010 Version)
- B9: Dreams Of Love And Literature (8-Bit Version)
- B10: Your Reality (No Vocals)
The soundtrack to Doki Doki Literature Club transforms and morphs as much as the game itself. The music is so directly evocative of an entire genre - the Japanese Dating Simulation - with its resoundingly quirky and upbeat tone, while also veering into territory that is almost impossible to encapsulate. In moments, those pastel notes of sunshine and cuteness turn into somber, emotional and deeply-wrought darkness/weirdness/something else. Therein lies the secret to this album's success - it is a brilliant exercise in the complete surrender of your soul. Very few soundtracks achieve such a feat, whereas Doki Doki does it with surprising and striking success.
The Item is out of Stock. We will send You an Email as soon as it´s available again if you click on "in Stock Mail"
- 1: Ghostsong
- 2: I Make Enemies
- 3: Etc
- 4: Slowly
- 5: Evryman For Himself
- 6: Fightscene
- 7: #2
- 8: Debt Collector
- 9: Chores
- 10: Get Out
- 11: Yet Another One For You
- 12: Smartass
- 13: You Win Some, You Tie Some
- 14: Armageddonsong
Picking up exactly where Disaster left off, Evryman For Himself features a full band and larger arrangements. Includes contributions from David Coulter (Damon Albarn, The Pogues), Fred Lonberg-Holm, Jason Toth (The Handsome Family) and the horns of Ralph Carney (Tom Waits, B52s). Second entry in the "Disaster Trilogy".
His work has inspired a diverse cast of collaborators that lie inside and outside his realm of alternative Americana, such as Jarvis Cocker, Thor Harris (Swans, Freakwater), and The Handsome Family with recent performances that include the likes of Rufus Wainwright, Andrew Bird, and Swans.
The Item is out of Stock. We will send You an Email as soon as it´s available again if you click on "in Stock Mail"
The Item is out of Stock. We will send You an Email as soon as it´s available again if you click on "in Stock Mail"
Sample Delivery Comes Along With It's 6th Release For Dj Suzmo's First Press. Easy Placed Samples And Loops, Breaks And Synth Breaking Tunes Inside. Run That Shit In Clubs Worldwide... Peace
The Item is out of Stock. We will send You an Email as soon as it´s available again if you click on "in Stock Mail"
- 1: Concerning The White Horse 09:46
- 2: The Unclouded Day
- 3: The Two Paths
- 4: Dark Matter
- 5: Lost Continent
- 6: Final Initiation
- 7: When The Sun Rises Do You Not See A Round Disc Of Fire
Experimental lute player Jozef Van Wissem and acclaimed film director and musician Jim Jarmusch have a working relationship that dates back to 2006, when they ran into each other on the street in New York City and quickly struck up a friendship. Van Wissem contributed to the soundtrack for Jarmusch's 2013 movie Only Lovers Left Alive, and the two have collaborated on three previous studio albums — Apokatastasis, Concerning the Entrance Into Eternity, and The Mystery of Heaven. An Attempt to Draw Aside the Veil is their second release as a duo for Sacred Bones Records, following The Mystery of Heaven, and its narrative picks up where that album left off.
Like The Mystery of Heaven, An Attempt to Draw Aside the Veil delves into the theology of William Blake and Emanuel Swedenborg, this time also exploring the work of Russian occultist and philosopher Helena Blavatsky. The album is mostly instrumental, so the dialogue between the esoteric thinkers who inspired it and Van Wissem and Jarmusch is expressed primarily in the song titles — fittingly arcane phrases like 'Concerning the White Horse,' 'The Two Paths,' 'When the Sun Rises Do You Not See A Round Disc of Fire.'
The Item is out of Stock. We will send You an Email as soon as it´s available again if you click on "in Stock Mail"
- 1: Concerning The White Horse 09:46
- 2: The Unclouded Day
- 3: The Two Paths
- 4: Dark Matter
- 5: Lost Continent
- 6: Final Initiation
- 7: When The Sun Rises Do You Not See A Round Disc Of Fire
Experimental lute player Jozef Van Wissem and acclaimed film director and musician Jim Jarmusch have a working relationship that dates back to 2006, when they ran into each other on the street in New York City and quickly struck up a friendship. Van Wissem contributed to the soundtrack for Jarmusch's 2013 movie Only Lovers Left Alive, and the two have collaborated on three previous studio albums — Apokatastasis, Concerning the Entrance Into Eternity, and The Mystery of Heaven. An Attempt to Draw Aside the Veil is their second release as a duo for Sacred Bones Records, following The Mystery of Heaven, and its narrative picks up where that album left off.
Like The Mystery of Heaven, An Attempt to Draw Aside the Veil delves into the theology of William Blake and Emanuel Swedenborg, this time also exploring the work of Russian occultist and philosopher Helena Blavatsky. The album is mostly instrumental, so the dialogue between the esoteric thinkers who inspired it and Van Wissem and Jarmusch is expressed primarily in the song titles — fittingly arcane phrases like 'Concerning the White Horse,' 'The Two Paths,' 'When the Sun Rises Do You Not See A Round Disc of Fire.'
The Item is out of Stock. We will send You an Email as soon as it´s available again if you click on "in Stock Mail"
- A1: Nights Out
- A2: The End Of You Too
- A3: Radio Ladio
- A4: My Heart Rate Rapid
- A5: Heartbreaker
- A6: On The Motorway
- B1: Side 2
- B2: Holiday
- B3: A Thing For Me
- B4: Back On The Motorway
- B5: On Dancefloors
- B6: Nights Outro
- C1: Our Raid
- C2: Lets Have A Party
- C3: The Chase
- C4: Holiday (Bedtime Dub)
- C5: Please Me
- C6: Over
- D1: Matthias Gathering
- D2: Heartbreaker (French Version)
- D3: A Thing For Me (Breakbot Remix)
- D4: Intro Thing (Demo)
- D5: Young Americans (Demo)
- D6: Output (Demo)
- D7: Das Booty (Demo)
As Metronomy work on their forthcoming sixth album, they take a moment to reflect on the 10th anniversary of their breakthrough album 'Nights Out'. Metronomy's Joseph Mount has delved into the archives for 'Nights Out: 10th Anniversary Edition' which will be released on February 8th on Because Music.
It features the original critically acclaimed album alongside a second LP which expands upon Mount's vision with a set of unreleased demos, rarities and b-sides - many of which make their first appearance on vinyl. Two of the highlights come with alternative versions which have become staples of the Metronomy live set: a bedtime dub version of 'Holiday' which takes it into a darker, glitchier direction, and a French-language version of 'Heartbreaker'.
Mount's Francophile leanings are also explored in Breakbot's remix of 'A Thing For Me', which contrasts French touch vibes with Mount's distinctly English-accented vocals. Previously issued on an exclusive Rough Trade bonus disc, 'Over' is an instrumental of cinematic scale, while the disc closes with four previously unreleased demos including the leftfield minimalism of 'Das Booty'.
Although Metronomy's 2006's debut album 'Pip Paine (Pay The £5000 You Owe)' was discovered by those in the know, it was 'Nights Out' that captured the imagination of a much wider audience. Mount achieved the seemingly impossible: he highlighted both the joyous atmosphere of a big night out and a taste of the resultant comedown in a set that playfully veered towards being a concept album.
About Nights Out Joseph Mount says: 'Oscar reminded me the other day how I said to him on completing Radio Ladio 'I think I've just written my first number 1'. I hadn't. We also reminisced about the day we borrowed the Honda Insight for the album artwork: I found the owner on an enthusiast chat room, we gave his daughter two Kate Nash tickets and a meet and greet with Kate in exchange for a few shots with the vehicle... simpler times. Shout out to Myspace.'
Metronomy's most recent album 'Summer 08' was released in 2016 to widespread critical acclaim. DIY described it as a 'pure-pop odyssey' and NME concluded, 'Mount has done it again. He could write music about the impact of Brexit on the UK's trade with China and make it sound amazing. He's that good.'
Metronomy bring 2018 to a close when they play Edinburgh's Hogmanay Street Party on December 31st. The 65,000 capacity show is headlined by Franz Ferdinand and completed by Free Love.
Promising/Youngster is the moniker for the Spanish artist Diego Cadierno. This new project arises from the need of rolling out his creations away from (but not far of) the dancefloor. Crunchy bases, fat basses, dreamy pads and analog and digital instrumentation join to form a landscape that could be named as a cross among IDM, Downtempo, Ambient and Shoegaze. The sound of Begin Again surrounds you in a distant world, it moves you to a place outside our planet Earth and touches you so deeply that you can almost feel the sound as tangible moment. This album contains a getaway of emotions, leaving IDM, melodic breaks, ambient sounds and shoegazers guitars as remote inspirations, perhaps as possible starting points. Julien Mier continues with the game of connections between the albums of the label by adding his particular and delicate sound with his remix. For this fourth reference, we have the Reykjavik606 duo and the producer Ylia as guest artists who enrich the sound of the album with their contributions. — 'Sin Hilo' means No Thread. We define our music as electronic music of untouchable rhythm and touching filament. Sin Hilo Records is our way of claiming music without ties, based on vocation, affection and the need for returning to craft work. We care about artists and we work based on mutual trust and unconditional respect.
The Item is out of Stock. We will send You an Email as soon as it´s available again if you click on "in Stock Mail"
The Item is out of Stock. We will send You an Email as soon as it´s available again if you click on "in Stock Mail"
Dispondant's Acid Jazz EP is a near-future paranoia soundtrack that could as well be the ending credits of the next Black Mirror season. Each episode has its minimal and focussed intent from captivating synth pads and flashlight 160 bpm beats to signalling 303 lines and anodyne chords. Yet it is the sum of its parts that made the Londoner's debut release on Defrostatica Records not just a fit but a label blueprint of modern footwork inspired electronic music.
"Couple killers in here" - Om Unit
"Serious!!" - Rohan G, DJ Mag Spain
"Super interesting music - will play on my radio show" - Laurent Garnier
"Will support club and radio" - Ray Keith
"Death, Acid Jazz, Jazz Solo, Sanctum. What a tunes! Wow. Perfect." - Lixx, Signaii FM
"Feeling this EP... Dance floor,radio, head nodders and smokers. This is perfect for a session at Soundpieces :)" - Spikey Tee
"Great as usual!! Big up Defrostatica!!" - JCC, drum and bass promoter South China
"Wow - one of the strongest releases yet! Great mix of clubby and 'listen at home' type bits. Going straight into my radio show this Weds" - Gary Brown, Footwork Manchester
"Jazzy minimal footwork! I quite liked the Acid Jazz, Jazz Solo & Sanctum. Mellow sounds for the chillout lovers." - Aki Otto, Sciencehki
"Lovely ep - will definitely play ACID JAZZ and SANCTUM" - Soulsurfer, Bassdrive
"Nice one! Strong support to Sanctum, thanks for sharing" - Thomas, Pulse FM
"Pushes boundaries of bass and dnb. Nice one!" - Bill DeBlase, Fresh Baked Goods on DNBRadio
"Really good ep with plenty of variation" - New Forms
"Accciidddd great ep!" - Felix HP Ritch, Vandal Records
"So original" - DJ Effect, Tech Collective
"Excellent release completely different to anything out there at the minute" - Mark, RTE Spectrum
The Item is out of Stock. We will send You an Email as soon as it´s available again if you click on "in Stock Mail"
Pulsating Drum & Bass creations full of swirling atmospherics, paranoid sample mangling, and melancholy pads aptly describes the material showed in Driftsystem's debut EP.
Inspired by worldwide 170bpm experimentation, droning ambience, and techno hypnosis. Driftsystem is the distillation of nearly 20 years in the music matrix as a dj, promoter, and producer of underground sonics.
The second part of the 'In Another Land' trilogy can be considered as the indispensable conceptual antipode to Part I. It's everything that Part I is not and vice versa. It's sculptural and it's not pursuing the idea of development, but it's neither static nor repetitive: The mostly short pieces, consisting of heavily treated snippets of recorded (electro-) acoustic instruments are circling around themselves, always aiming to show their core idea to the listener. The thing is the thing is the thing is the thing... just the perspective is changing.
The Item is out of Stock. We will send You an Email as soon as it´s available again if you click on "in Stock Mail"
Zeitkratzer member Reinhold Friedl revisits the piano guts some years after his much album Inside Piano (2011). While Friedl's first solo album defined the practice of playing on the strings of a grand piano," Music For Piano, ... Spring/Flower/Cracker/Stream" mixes piano with concrete and quasi-electroacoustic, freely moving from moving from plain motifs to walls of noise. A truly beautiful and ear-pleasing record that unashamedly shows the composer's and performer's love for the piano.
Reinhold Friedl studied the piano with Renate Werner and Paul Schwarz in Stuttgart, Alexander von Schlippenbach and Alan Marks in Berlin, composition with Mario Bertoncini (nuova consonanza) and Witold Szalonek. He has collaborated with musicians like Phill Niblock, Elliott Sharp, Alvin Lucier, Keiji Haino, Lou Reed, Carsten Nicolai, Laurie Anderson and has released more than hundred CDs.
All tracks composed and performed by Reinhold Friedl Recorded at the School of Music of the Aristotle University of Thessaloniki on the 11 and 12 March 2017 by Yannis Paxevanis Mixed by Yiannis paxevanis and Reinhold Friedl at Subway Studio Mastered by Nikos Lavdas at Kiwi, Athens Cover photo by Reinhold Friedl
The Item is out of Stock. We will send You an Email as soon as it´s available again if you click on "in Stock Mail"
The Item is out of Stock. We will send You an Email as soon as it´s available again if you click on "in Stock Mail"
Roy Garrett Born Roy Sambar In Colonia, New Jersey Arrived In New York City Hungry To Explore The Sex And Porn Scenes He'd Seen Advertised In The Village Voice's Classified Section. He Danced In Times Square Theaters The Gaiety, Ramrod, And Big Top Before Moving Into Adult Film. From 1979 Through 1983 Garret Starred In Ten Films, Five Of Them For Joe Gage, Including His Lead Role In 'heatstroke'. Throughout This Period Of Self-discovery, He Wrote The Suite Of Poems That Became 'hot Rod To Hell'. In 1982 He Recorded 48 Of The Poems With Haunting, Atmospheric Score By Man Parrish, Who Also Did Several Soundtracks For Gage. The Project Was Produced For The Stage And For Cassette By Manhattan Illustrator Robert W. Richards. Richards Calls 'hot Rod', 'a Searing Voyage Through The Labyrinths Of Modern Male Sexuality; It's Geography Ranging From Porn Theaters To Back Room Bars To The Intimacy Of Shared Beds. Only A Man Born At Exactly The Moment In Gay History That Garrett Was Could Have Lived Through And Conceived This Work.' Roy Garrett Tells His Stories Of Sex, Violence, Truth, And Illusion, A Visceral And Personal A Record As Any Of That Moment In Gay History Pre-aids. Joe Gage, Describes 'hot Rod' As, '...sweet Danger. This Is A Perceptive Look At The Underside Of Love. It Is Funny, Scary, Surprisingly Moving And Best Of All, Extremely Acute In Observing The Specifics Of The Human Condition.' All Poems Have Been Carefully Remastered For Vinyl By George Horn At Fantasy Studios In Berkeley. The Records Come Housed In A Jacket Designed By Gwenael Rattke And Includes An 44-page Full Color Magazine With All 48 'hot Rod' Poems Plus 44 Previously Unpublished Poems From Garrett's Archive. All Proceeds From 'hot Rod' Will Be Donated To Housing Works, A New York City Based Non-profit Fighting The Twin Crises Of Aids And Homelessness.
The Item is out of Stock. We will send You an Email as soon as it´s available again if you click on "in Stock Mail"
In 2007 Smith & Mudd's first album - Blue River - came out as a CD release. It's now been fully remastered by Simon Francis and will be released on a hand numbered limited edition gatefold LP.
"Blue River is a spine-tingling and evocative mixture of the organic and the electronic, the past and the future. It's an album you will want to hear again and again and as you listen more you will begin to notice the subtlety of the production, the clarity of the guitars, the warmth of the bass guitars, even the vivid colours the music paints in your mind while you listen. Blue River is a beautiful collaboration between Paul 'Mudd' Murphy and Ben Smith and features some incredible guitar work from Bob Klose, a founding member of Pink Floyd"
The Item is out of Stock. We will send You an Email as soon as it´s available again if you click on "in Stock Mail"
DIGGING IN THE BOXES IN DJ SPATTS LOFT WE FOUND NUMEROUS DAT TAPES IN GOOD CONDITION, SOME CONTAINED TRACKS FROM THE MIND BOMBING ALBUM. WE THOUGHT THEY WERE LOST SO IT WAS A NO BRAINER TO REMASTER THEM AND MAKE SOME OF THEM AVAILABLE ON VINYL.
Remastered and recut by MUSIC PRESERVATION SOCIETY
After a chance find of a DAT tape containing the vocal session for the classic 'Hardcore You Know The Score' by The Hypnotist, this EP was specially commissioned.
Remixes are provided by DISINTEGRATOR, New York City based DJ/Producers Oliver Chesler and John Selway) and INNERCORE (Matt Teksteppa Wilkins).
The Digital release in 2019 will have more mixes but we decided to keep this EP as Hardcore and true to the spirit of Rising High Records back catalogue of the early 90's as possible
Also included is the classic Original Mix.
QUOTE: Caspar Pound 'The More Nose Bleed The Better'
Remastered and recut by MUSIC PRESERVATION SOCIETY
The Item is out of Stock. We will send You an Email as soon as it´s available again if you click on "in Stock Mail"
- A1: Eric Chale, Ilona Chale & Michel Moers - Passé Dedans/Hymne
- A2: Michel Moers - Musaque Etnik
- A3: Daniel Plasschaert - Tue-Toi Dans Le Vent
- A4: Michel Moers - Ma Mère Etait Propre
- A5: Michel Moers - Il Est Huit Heures
- A6: Ilona Chale - Rester Dans Le Silence
- A7: Robert Altaber - Les 24 Heures Du Mans
- A8: Robert Altaber - Rotative
- A9: Robert Altaber - Trois Voyelles
- A10: Robert Altaber - Romances Sans Paroles
- A11: Marc Moulin - La Guerre
- B1: Ariel Kalma - Aman
- B2: Marc Moulin - Mes Chers Compatriotes
First time LP reissue on 180gr vinyl from this amazing Belgian compilation still oscillating 40 years later into the pop waves. This edition contains two new postcards as an insert, including liner notes by Michel Moers and the original lyrics of 'Aman' and drawing by Ariel Kalma.
The Item is out of Stock. We will send You an Email as soon as it´s available again if you click on "in Stock Mail"
- A1: Leben Und Arbeiten - Amanita
- A2: Malaria! - Your Turn To Run
- A3: Ausserhalb - Zeitzelle
- A4: Die Haut - Der Karibische Western
- B1: Aus Lauter Liebe - Pingelig
- B2: Mania D. - Track 4
- B3: Exkurs - Fakten
- B4: Christiane F. - Wunderbar (Optimo Edit)
- C1: Sprung Aus Den Wolken - Dub And Die
- C2: P1/E - Up And Above / Up And Above Dub
- C3: Franz Erlmeier & Fritz Köstler - Öffnen Sie Mal Ihre Tasche
- C4: Populäre Mechanik - Scharfer Schnitt (No. 1)
- D1: Andreas Dorau - Fred Vom Jupiter
- D2: Weltklang - Veb Heimat
- D3: Stefan Blöser - Voyager One
- D4: Matthias Schuster - An Rah Robeel
Strut Present An Exclusive New Compilation Curated By Optimo's Jd Twitch, 'kreaturen Der Nacht', Bringing Together Classics, Rarities And Oddities From Germany's Original Post-punk And Diy Scene. 1979 To 1984 Was An Era Of Particular Artistic Upheaval In Germany As Strong Subculture Scenes Formed In Many German Cities. Emphasis Was Placed On Expression Rather Than Technical Perfection, Artistic Impact Rather Than Skill. Diy Self-organisation Prevailed With The Establishment Of Small Record Labels And Independently Produced Records And Cassettes. Bands Experimented Across Genres And Consciously Abandoned The English-speaking Mainstream With German Band Names And Lyrics. 'although We Had A Small Underground
Scene, It Was Very Vibrant,' Explains Gudrun Gut Of Malaria! 'bands Like Die Haut, My Frst Band Mania D., Malaria!... We Organised Gigs Ourselves Or Friends Would Open A Gallery And
Have Bands Playing. We Hung Around Together In A Handful Of Clubs Like Risiko Or Dschungel And Went To Gigs At So36. West Germany Had Other Regional Scenes Too: Düsseldorf And
Köln Around Der Plan And The Ata Tak Label And There Was The Hamburg Side With Abwärts. Germany Didn't Have A Real Music Industry Like The Us Or England Back Then.'
This New Collection Is A Personal Selection From Jd Twitch, Built Over Years Of Playing The Tracks In Club Sets. 'it Is Not Designed To Tell A Defnitive Story Of What Was Going On In
Germany In This Era,' He Explains. 'rather, It Is Simply An Arbitrary Collection Of Records I Adore From A Specifc Era With A Specifc Attitude That Hopefully Together Sum Up Some
Of The Musical Undercurrents In Germany At That Time.'
The Package Features A Host Of Rare And Unseen Photos From The Period Along With Extensive Interviews With Artists Including Beate Bartel (mania D.), Christoph Dreher (die Haut),
Michael Hirsch (p1/e) And Thomas Voburka (weltklang). All Tracks Are Remastered By The Carvery With Artwork By Optimo's In-house Design Man Andrew Beltran.
- 1: Rekordfahrt Negativ Seite A Intro
- 2: Agents In Infrared - Kalt Wie Eis
- 3: Mitra Mitra - Play
- 4: Da Da Pogrom - Walk Away
- 5: Konstantin Unwohl - Trier
- 6: Spirit Of Venus -Break The Walls Of Silence
- 7: Laker Herzog - Waiting In Line
- 8: Rekordfahrt Negativ Seite B Intro
- 9: Attack Budgies - Scilence The Boss
- 10: Pure Ground - Final Dust
- 11: Convex Model - Nie Frei
- 12: Qek Junior - Ich Bin Raus
- 13: Silent Signals - Taste Your Joy
- 14: Spielzeuge - Tier
The Item is out of Stock. We will send You an Email as soon as it´s available again if you click on "in Stock Mail"
RAMP is proud to welcome Visionist through it's esteemed halls.
*Appearing on the scene in 2011, new school Grime producer Visionist's dark, stripped down, emotive sound has won fans from Oneman, Benji B, Kode 9 and Pearson Sound to fellow RAMP artist Zomby. Visionist arrives on RAMP with "M" & " Secrets".
Little Beat Different deliver another album-length release, this time, it's a young hardworking Italian Davide, found in the deepest abysses of Soundcloud, providing tracks that are beyond conventional forms of house music and techno, ranging somewhere between ancient ritual rhythms and early morning afterparty club beats. As a bonus, Aussie newcomer (or is he) Hence Therefore, who with every single one of his releases shapes up his unique sound, comes up with his trippy take on UK bass with his remix of Waiting Grounds.
The Item is out of Stock. We will send You an Email as soon as it´s available again if you click on "in Stock Mail"
On Epitaph things are different - Jay's voice croons crystalline over goth futurism for the first time on record (if you haven't heard of Ku....) - he sings one of the oldest Greek songs ever written and has spent the last year doing impromptu vocal covers of Tricky tracks in Cambridge pubs. And did you notice the tracks don't have dub in the title any more
This the first proper propersolo LP from Jay Glass Dubs - a widescreen vision of 4AD nightmares, ballads for River Styx crossings and echoes that never end. It's This Mortal Coil if they knew about dungeon synth and Metalheadz and still thought dub techno was boring as fuck.
Epitaph follows his 2LP retrospective of 'the tape years' 'Dubs', on Not Waving's Ecstatic Recordings; and his 12" mini-LP with Leslie Winer on Bokeh early in 2018. It's his 5th and no way final release for Bokeh (do you remember BKV 002 the slowest dancehall mixtape ever made) Realised with help of Greek vocalist and performing artist Yorgia Karidi and a special saxophone guest spot from Ben Vince (Curl, Where To Now, Hessle Audio). Bokeh graphic visionary Patrick Savile's sensually airbrushed and peeled lemon closes this funeral casket of all the things you thought you knew about Jay Glass Dubs.
The Item is out of Stock. We will send You an Email as soon as it´s available again if you click on "in Stock Mail"
Myriam Bleau is a composer, digital artist and performer based in Montreal. She creates audiovisual systems that go beyond the screen, such as sound installations and performance-specific musical interfaces. Her hybrid electronic practice explores music performance as a codified cultural manifestation and recontextualizes pop culture elements and music history tropes. For 'Lumens & Profits' Myriam has exported this ethos towards pure sound design, deconstructing a palette of familiar musical forms into 8 pieces of wandering, weightless movements; where Vocal samples and percussive rushes launch themselves from empty space, repeatedly shattering any vibe you were about to ease yourself into. Rhythms scatter, violently collapse, and pick themselves up again grinning with hands aloft, sprinting towards the light.
This is the sound of an artist who clearly has a deep interest in modern tropes of UK bass music and contempory electronic composition, but due to Myriam's historical grounding as a tactile, experimental audio visual artist these genres become uniquely filtered through a performative, Musique Concrete focused lens. In this sense the pieces end up as somewhat hybrids, absorbing Myriam's rich performance based musical history and sweeping into the mix the outer corners of avant garde 80's sampler experiments, Hip-Hop Turntablism, and classical elements. With 'Lumens & Profits' Myriam has managed to create something which sounds distinctly fresh in approach, whilst managing to playfully & respectfully nod towards a tidal wave of cultural movements.
'Lumens & Profits' is heavily influenced by Myriam's own 'Musical Spinning Top' A/V performance 'Soft Revolvers' (viewing a section of the spellbinding performance does the piece far greater justice than I could ever try to clumsily put into words). Whilst inspiration was gleamed from the performance Myriam is keen to separate the two projects, explaining - 'While composing these pieces, I was very occupied by the idea of modulated speed or tempo that came from my spinning top performance. Seeing instruments on different tempos that fluctuate rather than run on different strict patterns. I tried to imagine freely moving instrumental lines that only momentarily align, rather than a grid or tempo that would control all the elements. A lot of the pieces rely on algorithmic arpeggiation (custom max patches), as a way to create processes that control the speed and timbral width of sounds dynamically.'
Fans of Lee Gamble, Tomoko Sauvage, Mark Fell, RKSS, Holly Herndon, Christian Marclay take note here, dive in and get lost.
The Item is out of Stock. We will send You an Email as soon as it´s available again if you click on "in Stock Mail"
Finally the vinly edition of this great album originally released in 2013. Limited Edition honey yellow clear vinyl.
For this long-player, Mac has harked back to the good ol' days of analog, employing numerous vintage instruments to create a wholly electronic yet warm, soulful sound.
Marc's Detroit techno influences are ever present on this release, with more than a hint of that unmistakable 4Hero vibe. That said, there is something that makes 'The Third Adam' undefinable - is it house, is it hip-hop, is it beats, funk or electro Who knows - but that's what makes it so remarkable - it's in a genre all its own. There are few artists out there that can draw heart-warming soul from cold, dusty electronics like Marc Mac can.
Stop Look Listen
The Item is out of Stock. We will send You an Email as soon as it´s available again if you click on "in Stock Mail"
Following his 2017 solo debut EP, "Resisting in the Darkness", Tyler Dancer takes a step toward the light in his second outing for DBA, "62 Miles High".
Written in Hasselt, Belgium, "62 Miles High" finds the Shake-collaborator drawing upon his Detroit and Midwest influences to reveal another page from his sonic journey.
The record you are holding in your hands is a previously unheard masterpiece of Israeli multimedia artist Ami Shavit. As a professor of both philosophy and art and established kinetic artist in the 1970s Shavit was fascinated with new and interactive technologies. While mostly focusing on visual art and mixed-media installations, a trip to New York in 1972 introduced him to synthesizers and triggered his curiosity to do some explorations into the world of music or "sound" as he preferred to call it.
Ami's research was focused on the concept of meditative music that would help people to relax and create a cosy mood associated to the alpha brain waves and biofeedback. Before starting his artistic career, like all Israeli citizens, he had to serve in the army to his personal regret. Shavit had an operational position, which meant a high probability to get involved in a so called 'hot situation'. When in 1973 the Yom Kippur war broke out, Ami was enlisted again and got the unfortunate opportunity to encounter, in Hanoch Levin's words 'the dead'. Being an operation officer he was in charge of evacuating Israeli wounded officers from battlefields to hospitals. Some 6000 injured men passed through us during that war, he recalled one year later in a newspaper interview.
'I witnessed some sights that I can hardly forget. On the one hand I felt that as an artist I had to express the war events, on the other hand I felt that this is an almost impossible mission. Only Goya and Picasso, in his Guernica, addressed this topic successfully.'
Yom Kippur is the final and seminal of Shavit's sound experiments ever recorded and now finally available to the world. We believe that this is an extraordinary strong piece in which the hectic moods and terrific experiences of war are deeply transmitted to the listener. May all soldiers, who are often forced to go through traumatic experiences beyond their own will, find ways to artistically digest and process the unwanted memories.
Ami Shavit was born in 1934 in Tel Aviv-Jaffa. Known as visual artist, his work involves in creating virtual environments with optic and kinetic art, including structures worked by electricity, moving tubular configurations illuminated by colored lights. He published In Alpha Mood in 1977 on Amis records, his own record company, at 500 copies, republished by Finders Keepers Records in 2015 and Neural Oscillations And Alpha Rhythms in 2018. Yom Kippur is his ultime recordings.
Supercharger head honcho Black Orchid goes in for some seriously deep and authentic sounding
breakbeat driven D&B under his Ark X moniker. X2LV is basically the perfect representation of the
vibe Diamond Life was set up for in the first place: lush pads, solid beats and a slightly euphoric yet
melancholic feel throughout.
On the flip Myor Massiv and Diamond Life stalwart FFF drops one of his prettiest cuts to date.
Know How showcases the breakcore legend's ability to keep things sparse and beautiful, a slow
burner of epic proportions.
- 1: First
- 2: Baby Blue
- 3: A Skeleton
- 4: Fourth
- 5: Arms Down
- 6: Sixth
- 7: Lust
- 8: Differently
- 9: I Know You Feel The Same
- 10: Do Do Do
Hailing from Suuns, Canadian Ben Shemie offers up his first solo work, A Skeleton. An experimental pop album of cold synthetic sounds with touches of psychedelia.
Based on his live, itinerant experiments, the whole album was recorded in a single take with no overdub. Shemie has left traces of the atmosphere of each recording space, adding an element of chaos and unpredictability alongside his masterful/dexterous manipulation of the equipment.
The voices and instruments sound as if they were drawn from a not-too-distant future in which artificial intelligence has taken over human life and mutated into an artist. The album recounts the random wanderings and metaphysical rêveries of a skeleton - the fantasy muse of the machine, devoid of sex or race, a neutral entity.
The refined, minimal sonic narration is executed with astonishing precision and sensitivity. With A Skeleton, Shemie has definitely painted us a refreshing avant-garde picture.
The Item is out of Stock. We will send You an Email as soon as it´s available again if you click on "in Stock Mail"
- A1: Atlas (Feat. The Clerk)
- A2: Let Me Go (Feat. Nonku Phiri & Mr. Carmack)
- A3: Eventually (Feat. Alex Rita & Bison)
- A4: On Top (Feat. Zanillya, Capadose & The Ruffest)
- A5: Out Of Sight (So Right) (Feat. Rodes)
- B1: Take Off (Feat. Princess Nokia)
- B2: Whole Night (Feat. Okmalumkoolkat & Lewis Cancut)
- B3: Paris - Marselha (Feat. Cachupa Psicadelica)
- B4: Made Of Gold (Feat. Skip&Die & Fellow)
- B5: Reserva Pra Dois (Feat. Mayra Andrade)
Lisbon-based DJ and producer, Enchufada label head, Red Bull Music Academy alumnus and Buraka Som Sistema co-founder Branko is ready to embark on a whole new adventure. The renowned multifaceted artist went on a sonic journey around the world to connect with some of the most exciting music scenes out there, meeting and collaborating with a new generation of artists to create his debut solo album 'Atlas'. After giving listeners a first taste of his exciting new work with singles Eventually (feat. Alex Rita & Bison) and Let Me Go (feat. Nonku Phiri & Mr. Carmack), the globetrotting producer now invites you to listen to solo debut album 'Atlas' in full. 'Atlas' sees Branko becoming part of an international network of artists and shaping a solid body of work that feels his own, while at the same time being truly communal and global. This can be clearly felt both in the impressive number of artists who lined up to participate - over 20 collaborators across 5 different cities - and the hybrid nature of the music, which in true Global Club Music style connects distinct geographies and musical genres to create something new for the world's dancefloors. Afro-house, zouk bass, gqom or baile funk are treated as pieces of a larger puzzle, put together to create a new tropical-flavored musical picture for the digital age. After hours of work in Red Bull Studios in Amsterdam, Cape Town, New York, São Paulo and Lisbon - documented in the 'Atlas Unfolded' webisode series - recording vocals, laying down beats and tweaking samples, 'Atlas' comes to life and the final list of collaborators is as long as it is culturally rich. From Mr. Carmack to Okmalumkoolkat, Mr. MFN eXquire, DJ Sliink, The Ruffest, Princess Nokia and Lewis CanCut - to name only a few - 'Atlas' is a veritable 'who's who' of the Global Club Music scene, all handpicked by Branko to help him bring his colorful artistic vision to life.
The Item is out of Stock. We will send You an Email as soon as it´s available again if you click on "in Stock Mail"
Introducing the 3rd Myor sublabel, Faces Of Bass is all about the 4x4 hardcore styles. Knock Out has a rather rushy feel to it: the combination of high pitched, repetitive key riffs, acid bleeps and layered breakbeats, supported by 4x4 kickdrums and enough low end to rattle your trunk carries the tune deep into heyday UK Rave territory. The Dutchman's gabber roots are slightly more evident on My Bizz, which features a harder, more distorted bassdrum, relentless Juno synth retriggering, rap slapper vocals and ruffneck Amen patterns, making for a hardcore jam that wouldn't have sounded out of place at a 1995 edition of Thunderdome.
The Item is out of Stock. We will send You an Email as soon as it´s available again if you click on "in Stock Mail"
The Item is out of Stock. We will send You an Email as soon as it´s available again if you click on "in Stock Mail"
Originally released on cassette in the summer of 2016 on the Geographic North label, In Summer marks a turn for Jefre Cantu-Ledesma. Here we see him fully embrace the past, equipped with LinnDrum, chorus drenched guitar and rhythmic bass lines. At moments, In Summer feels like lost demos of Durutti Column jamming with The Cocteau Twins. But not to worry, Jefre still delivers doses of what we know him for - interspersed field recordings, tape manipulations, and free modular experiments to keep us on our toes.
Kevin Lozano from Pitchfork described In Summer as 'some of the most emotionally evocative noise music of the year" and we couldn't agree more. This marks the first LP release for In Summer, as well as the first LP for Psychic Troubles Tapes with a limited run of 500 and full color sleeves donning the photography of Jonathan Sielaff
The Item is out of Stock. We will send You an Email as soon as it´s available again if you click on "in Stock Mail"
Michigan artist John Beltran's 13th studio album and 3rd on Delsin is his most complete and personal work yet. Written largely on modular synthesizers for the first time, it melts 90s intelligent techno with post rock and ambient with leftfield downtempo. The seventeen tracks draw on his expert knack for sound design; for melody and atmosphere and make for yet another hugely absorbing affair.
Icons Karen O and Danger Mouse unveil their debut recording as a duo, 'Lux Prima,' today—listen here. The song, out today on BMG, is the first to be released from a forthcoming joint album.
'Lux Prima is the first song we wrote for the record,' says O. 'After making music for the past twenty years and embarking on making this record with Danger Mouse I knew a couple things: one was that the spirit of collaboration between us was going to be a pure one, and two was that the more I live the less is clear to me. When you create from a blurry place you can go places further than you've ever been. I think we both were excited to go far out.'
Limited edition 12" featuring 2 extended Harlem River Dub remixes by Aaron Coyes / Peaking Lights with art by Robbie Simon. Digital includes an extended version of the original track. Edition of 1,000 on black vinyl.
'I wanted to do something to honor the title track off of my debut album, Harlem River, turning five years old this year. Its been very good to me over the past half decade as well as a staple in my live show. I've asked Aaron Coyes from Peaking Lights to breath some new life into it and give it a remix and I'm very happy with the results. This December I will be performing an hour long version of the song featuring many special guests. I wrote the song to be about new explorations, and it continues to give me—year after year—just that.' - Kevin Morby
Second Release for La Chinerie's Comic Sans imprint. For this one we invited two brothers Antoine & Matthieu for a split work dedicated to the famous Tekken game.
First side is Antoine's which only ability at the game was to spam his opponent with the now very famous "dragon kick" technique
Second side is Matthieu's (aka $turmtruppen 1917) who has always been fascinated by Yoshimitsu's hability to commit suicide during a fight.
The Item is out of Stock. We will send You an Email as soon as it´s available again if you click on "in Stock Mail"
For Moloton's ninth outing, they're welcoming Orphan Ann with their debut LP 'The Practice of Surrender'.
The duo, consisting of DIY veteran Anja Enerud (Masskultur collective) and Sofia Al Rammal Sturdza (SARS, Född Död) burst onto the scene with their pitch-black take on synth music, combining sharp, penetrating vocal chants with atonal drones and haunting drum machine patterns. Orphan Ann has previously released their music on the Danish label Posh Isolation, where they contributed with four tracks to the 'You And Me Now' cassette compilation. They have been performing their live show at various stages around the world, including MUTEK in Mexico City and Norbergfestival in Sweden.
'The Practice of Surrender' consists of nine tracks, all recorded, produced and mixed by the duo themselves in their studio collective Tropiska Föreningen in Stockholm. It is indubitably a proof of a healthy Stockholm scene, where both Moloton and Orphan Ann are leading the way, pushing the Swedish experimental sound forward with a glare.
The Item is out of Stock. We will send You an Email as soon as it´s available again if you click on "in Stock Mail"
Piano Music is a release with two short tracks which are based on piano recordings Orphax made at De Ruimte in Amsterdam Noord in Mid and End of Summer 2017. On this release musically Orpax breaks with his other work by using more melodic ambient sounds and focus less on the drone. It is one of his most personal works to date. The music on this 7" is about closure and trying to leave things behind, how difficult this might sometimes be. It is about making the wrong decisions and regretting those, but also learning to cope with these and to move on.
The Item is out of Stock. We will send You an Email as soon as it´s available again if you click on "in Stock Mail"
The Item is out of Stock. We will send You an Email as soon as it´s available again if you click on "in Stock Mail"
The Item is out of Stock. We will send You an Email as soon as it´s available again if you click on "in Stock Mail"
Atmosphere EP is Rising Sun`s fifth release on Fauxpas Musik and we can say quite safely that Steffen Laschinski fueled a few identifiable obsessions over the years for those familiar with his work. it probably won't feel like uncharted territory when they'll hear the title-track.
Vinyl tastes better
The Item is out of Stock. We will send You an Email as soon as it´s available again if you click on "in Stock Mail"
third release of studio mule's new project with miyako koda aka dip in the pool.
following the cover versions of ohnuki taeko's carnaval&mariah's shinzo no tobira,we made the new version of japanese pop ambient classic 'face to face by yumi murata'.
extended edit on a side is full of the respect for the original version and ambient version on b side is simply emotional.
the first album of studio mule is coming in the beg of next year.
stay tuned.
In the search for new sound grammars, Wesqk Coast proposes a linguistic approach to music in which sounds are words, signs. As for a neo-language, informality, contamination, deviations and its gradual normalization trace the dynamics of control and re-absorption of expressive forms.
'S.T.A.S.H. ...well, there is no actual meaning behind the title's acronym, I am interested in its cryptographic potential.. like language, music works through a combination of minor units, capable of unpacking an endless world of meanings...'
When asked to give some thoughts about his work, the reply was a slew of stock images and short quotes: text analytics, psychometrics, data storms, predictive technologies, ethics of psychological profiling... S.T.A.S.H. is revealed through rapid suggestions and music hybrids in which overload of inputs and frenetic absorption re- elaborate into a true personal stylistic mash - today's media.
The digital ambient vocal pads and sparse rythmics of 'Generation' open to implode into the Bertoia-style metallic tones of splendid 'Tek', anticipating an album that developes as a continuum. Title track 'S.T.A.S.H.' starts from augmented computer game scenarios to collide, in second half, with extra-fast triggered rattling drums - everything reminds of Piteous Gate. Named after the infamous italian politics sex scandal, 'Ruby Gates' resonates with its thorny inspiration through a Twin Peaks sample-based sloppy melody and vocal interventions. The dream-like lullaby of 'Aicha' tests a different syntactic palette to break the tension and introduce the ancient-futurist voices and nervous rythmics of 'Cane Rabbioso'. Melancholic and post-modern 'Estate Nera' slowly builds up like ambient and dismantles into a futuristic dub - word up.
[D] a4. Ruby Gate [Twin Peaks Edit]
The Item is out of Stock. We will send You an Email as soon as it´s available again if you click on "in Stock Mail"
Xiu Xiu's new album called "Girl with Basket of Fruit" is coming out via Altin Village & Mine in Europe. "Girl with Basket of Fruit" is imbued with the agitation, tension, sorrow and anger that has permeated the daily lives of so many over the last few years. It was produced by Xiu Xiu's Angela Seo and Greg Saunier of Deerhoof. Xiu Xiu is Thor Harris, Jordan Geiger, Angela Seo, and Jamie »Butch Jenny« Stewart.
It could be handfuls of reds It could be turning Caravaggio's Boy with Basket of Fruit to face the wall It could be a commission by the Guggenheim entitled Deforms the Unborn It could be the demon Vetis, whose friends call Him The Life Promiser It could be that in 1918 a pregnant Mary Turner was hung upside down from a tree by a lynch mob while they cut out her fetus & that this could happen today, as it did then, without consequences for whitey It could be handfuls of natural pearls It could be collaborations with master Haitian drummers It could be doing the wrong thing together forever It could be long lists of how The Devil's acts towards children before, during & after their possession It could be short lists of produce, insects & imagined blues musicians It could be handfuls of an insane 9 year old's feces smushed on the lunch table It could be a psychedelic Chicago house song about a pig & about your parents It could be your dad's new husband gave you his boyhood viola It could be a collaboration with master Yoruba drummers It could be handfuls of cactus spines & a poison dart It could be your sister has cancer & they keep chopping parts of her body off It could be a conscripted arco bass piece that was a dedication to Turkish feminists It could be Jack Smith has a film called Normal Love It could be scisssssssors, air conditioner tubes, glasses of ice & seashells It could be handfuls of hot pink Make Noise 1/8th inch audio cables It could be that Nature is making it clear to us that we deserve it and that we are making it clear to Her that we are ready, ready to go It could be a short novel called The Rhythm Section Talked about Drugs, The Horn Players Talked about Ass & The Strings Talked about Money It could be improvised vocals by Elliot Reed & orchestrated vocals by Eugene Robinson It could be that European religious paintings of male martyrs depict them surrounded by chubby, adoring angels, everyone's tearful mothers & converted sex workers dutifully sponging out their holy & shallow wounds It could be that European religious paintings of female martyrs depict them with their nipples being torn off, throats branded & their naked torsos flayed while they are totally alone aside from the men torturing them It could be handfuls of Diamanda Galás & Roy Orbison action figures It could be that despite the confusion of this life, people who can still truthfully call themselves human try to push through 2019's collecting horror It could be slowed down & fuzzed out field recordings of disappearing frogs It could be flat purple & black or glossy black & purple It could be mescal in a bottle & baby on a boob, hair dyed blonde for nobody, nobody move It could be handfuls of that you just have to stop being a wuss & deal with it It could be...
Recorded by Butch Jenny Stewart at Nurse Additional recording by Tara Jane O'Neil Mixed by John Congleton at Elmwood West Mastered by Lawrence English at Negative Space Produced by Angela Seo and Greg Saunier
The Item is out of Stock. We will send You an Email as soon as it´s available again if you click on "in Stock Mail"
Another root ready to bloom has been found in Yann Polewka. His opener is a filter laden, vocal drenched affair that holds the ever present RFB groove. All I Dooo is next and holds that similar french filter style this one focusing on heavy strings and driving drums. The B Side sees up ramp up a gear, Luv Me Baby is looping and relentless. The piano and bass loop is short and repetitive but is constantly changing with filters vocals and interweaving percussion, this one works great on the dance floors. With B2 we see RFB take an unusual path for the label. All around is reminiscent of drum and bass almost liquid vibe with seductive vocals and ramped up tempo.
The Item is out of Stock. We will send You an Email as soon as it´s available again if you click on "in Stock Mail"
Drawing In Sound is a live improvisation, created by sound artist Andreas Usenbenz and illustrator Christoph Lammers for the exhibition opening of "Wiese" ("meadow") by artist and curator Andreas Pytlik at Städtische Galerie Rosenheim in the spring of 2018.
Prior to the performance, the artists exchanged ideas, drawings and sound improvisations to find a way of approaching the topic of 'meadow' in the context of contemporary drawing and contemplative soundscapes. During the performance, illustrator and sound artist entered a dialogue: Usenbenz created subtle sound textures and phonographic collages of rustling hay, records, guitar sounds, field recordings, tapes and effect devices.
Lammers opened all senses to both space and sound. Reacting intuitively, focussing on the moment and with great physical effort he composed his images, formed structures from lines and shapes. Using charcoal, ink, brushes and his bare hands, he filled the 7 by 4 metre canvas, vigorously at times, then almost delicately, providing stimuli in turn picked up by Usenbenz. Ultimately, this "conversation" between the two artists gave rise to a different interpretation: Everything grows of its own accord.
Played and improvised by Andreas Usenbenz, using objects, lo-fi microphones, contact microphones, field recordings, guitar, ebow, looper, ipad, dictaphone, cassettes, tape loops, op 1, field kit. Drawn and performed on a 7 x 4 m canvas by Christoph Lammers, using different objects, ink, charcoal, brushes and his bare hands. Recorded live at Städtische Galerie Rosenheim. Additional sounds recorded and edited at home.
The Item is out of Stock. We will send You an Email as soon as it´s available again if you click on "in Stock Mail"
'Zonder Stroom', meaning 'sans electricity', was a short-lived program curated by Extrapool with performances that were completely without electricity (no amplification, no lights, no fridge) and one bleak and damp winter's afternoon we drank coffee and decided to use all the electricity there was, recording any keyboards, synthesizers and electronics they could lay their hands on. Then they tried to make sense of that day. This album features mixes and remixes of one joyful and intensely creative session.
Richard Youngs has been involved with music for most of his life. He discovered the power of the art form by thumping the family piano as an angry 5 year old. In the intervening 45+ years he has attempted to harness the same experimental, naive, playful power in his recordings and live performances. He has performed floor spots at Hertfordshire folk clubs, and worked with members of the Royal Conservatoire of Scotland. He has recorded a modern pop album ('Beyond the Valley of Ultrahits'), and a score for the BBC SSO ('Past Fragments of Distant Confrontation'). He was commissioned to write music for the art film 'The Poor Stockinger, the Luddite Cropper and the Deluded Followers of Joanna Southcott', and his music has appeared in the 2013 feature film 'Drinking Buddies'. He is the drum machinist of the Flexibles, singer of AMOR. He is classically trained in piano and guitar, but musically he grew up in the shadow cast by punk rock. Adopting guerrilla recording techniques, the independent D.I.Y. ethic is at his core.
Frans de Waard has been producing music since 1984 (Kapotte Muziek, Beequeen, Goem, Zebra, Freiband, Shifts, Modelbau, etc.). In 1984 he started his own record label Korm Plastics, releasing music from Arcane Device, Asmus Tietchens, Jim O'Rourke among others. He has worked for the pioneering Dutch tape label Staalplaat (1992-2003) and since 1986 as a reviewer for his own publication Vital (now Vital Weekly), a magazine which has been an online source for underground music since 1995, and which celebrated its 1000th issue in 2015. In 2016 Timeless published in France his first book, an autobiography of life in Staalplaat titled This Is Supposed To Be A Record Label. His interests in music creation ranges from ambient to noise to what he describes as 'silly disco music'. He has played concerts in Europe, USA, Canada, Russia and Japan, and collaborated with Steven Wilson, Jaap Blonk, Andrew Liles, Radboud Mens, Keiji Haino, Pan Sonic and others.
Peter Johan Nÿland is best known for his work with intensive synth duo Distel, avant-garde leviathan Hadewych and melancholic ambient project Norn. Other ventures include collaborations with the likes of Dead Neanderthals and Trepaneringsritualen. Next to these involvements he does the odd audio engineering job and until recently worked as a composer for television documentaries and other media. Early exposure to synthesiser experimentation, combined with the plethora of percussion sounds found in metal school fences and hypnotising phase-shifting pencil-tapping on desks removed his ability to just take sounds for granted. Keep your kids away from said objects, lest they turn out the same.
The Item is out of Stock. We will send You an Email as soon as it´s available again if you click on "in Stock Mail"
Jasss makes her head and body-turning album debut with Weightless, an absorbingly stark and spiky set of industro-dub concerns riddled with heavy inspiration from African rhythms, jazz and concrète electronics. After a trio of acclaimed 12's for Berlin's Mannequin and Amir Alexander's Annunaki Cartel since 2016, iDEAL now give Jasss room to consolidate and expand her grizzled dancefloor structures to a full length episode that brutally dovetails with Joachim Nordwall and co's unforgiving but compelling take on contemporary noise and industrial musics.
Very much an antecedent of Spanish industrialists such as Diseño Corbusier, Xeerox / Krishna Goineau, or Mecanica Popular/Randomize, Jasss firmly builds on that heritage with a uniquely pensive balance of percussive suss, synthetic bite and reverberating spatial dynamics that makes her music heavy-as-sin and deliciously deft with it, patently forgoing Industrial music's angry guy glare in favour of far more feminine and latinate pressure systems.
She does so with an aching, puckered patience in the opener, Every Single Fish In The Pond, escalating from a lone cymbal motif and location recordings to a pulsating darkroom boldness by the end of an incendiary scene-setter, before really getting her fangs in with the clenched but driving EBM torque of Oral Couture, recalling a spiked Toresch or CTI hovering at the darkroom's entrance.
From here on in a dream sequence of events take place, morphing from febrile, hash-induced triplet pirouettes in Danza thru the martial free jazz/industrial cut-up of Cotton For Lunch, to a definitive apex of sprung, stepping cybergoth in Weightless, with a pause for Alberich-like reflection on Theo Goes Away, but the voodoo rises once again with the druggy swagger of Instantaneous Transmission of Information, and her stoic, blunt-edged mauler, To Eat With Dirty Hands.
It's rare to hear industrial music done with such variation and individual distinction as Weightless, making it shine in a field so often associated with greyscale and monotone signatures..
The Item is out of Stock. We will send You an Email as soon as it´s available again if you click on "in Stock Mail"
In February 2017 Moving Furniture Records released "1", the first LP by Radboud Mens and Matthijs Kouw. The album consists of two long drone tracks that make you forget music is a time-based art. Music that immerses you in a warm bath of frequencies that are evolving slowly around you, revealing you all sides and details of a sonic sculpture.
With this second release, which is simply titled "2", Mens and Kouw continue their exploration of long-form drone. By using precisely tuned analogue synthesis, Mens and Kouw create a rich tapestry of drones and slowly changing environments. To the careless listener, nothing much seems to happen. However, an attentive ear will reveal a rich variety of resonances and sonic artefacts. Starting as a deep and warm drone music both pieces gradually develop into a collage of textures and frequencies that are carefully moving in and out of the drone. This record is the second of a two-part album that was recorded live in the studio in December 2014, released in an edition of 300 LPs that are packaged in reversed sleeves and are provided with a digital download.
Matthijs Kouw is a sound artist exploring the relation between movement and stasis. Using a wide variety of source material that includes field recordings, amplified objects, software synthesis, and analog synthesis, Matthijs has worked on music for theatre, dance, and film, as well as sound installations. He has released music via various outlets, including IO Sound, erstwhile tape-label Grel and Moving Furniture Records. Matthijs lives in Utrecht (Netherlands), where he is slowly working on a new solo work.
Radboud Mens is a sound-artist, composer and sound designer who is working with sound since 1982. He started creating noise-machines in 1988. In the early 90's he attached contact-microphones to dog's brushes that he used to destroy vinyl records by scratch-playing them, boosting the signal through broken cassette- decks and recording the results. Currently, like for example for his album Cycle (2015), he builds his own acoustic instruments and sound-installations. These instruments and installations are played live through a computer for real-time processing and then recorded. The recordings are used in new compositions. Radboud Mens has worked with a broad variety of sound artists and composers, including Stephan Mathieu, Janek Schaefer and Timeblind, voice-artist Jaap Blonk, guitarist Dan Armstrong (as Fitness Landscape), Michel Banabila, Mark Poysden (as Alignment), Craig Ward (ex-Deus), and Matthijs Kouw. His music has been released by Staalplaat, Mutek_Rec, AudioNL, ERS, Bake Records, Noise Museum, Takashi Mobile, Tapu Records and Touch. In live situations he collaborated with video-artists such as Marco Douma, Remco Schuurbiers, Bas van Koolwijk and Jpech.
The Item is out of Stock. We will send You an Email as soon as it´s available again if you click on "in Stock Mail"
Debut album by Düsseldorf based electronic music producer Pondskater aka Axel Ganz.
Experimental Music. Music with experiments. From the mind for the gut. Your gut gets affected a lot during the 38 minutes of this remarkable album. Restlessness is evoked. It is disturbing with its cold energy and its unfolding abstract sound layers. These compositions evoke questions: Has balance been lost and should be re-established Or is it all about finding the right way of balance for a very first time Is there any fruitless kind of balance, that should be undone Which price is to pay, which effort to make defending balance against those unsteady forces that threaten it
The eight tracks of the album give answers to these questions. They all are created with an obstinacy, that has yet been typical for Pondskater's earlier projects. "Balance" is an excentric and wilful orbiter inside the Düsseldorf electronic galaxy. Pondskakter's tunes are puristic, cold and surprisingly little hesitant to make references to Düsseldorf pioneers Kraftwerk and abandon them at the next moment. The most startling moments of the record, however, are both its humour and melancholy that radiate through all the pieces. Pondskater has managed to create an extraordinary coherence of both.
"Balance" has a strange sparkle around it, seeding an impression that lasts after repeated listening: It is the fascinating sparkle of an ice-blue coloured piece of jigsaw against the larger background of contemporary electronic music.
The Item is out of Stock. We will send You an Email as soon as it´s available again if you click on "in Stock Mail"
- A1: Doomsday Survival Kit
- B1: El Khawaga
- B2: The Spy Who Spoke Too Much
LP DELUXE EDITION includes: Pink vinyl / Poster / Redeem code, Ltd to 300 copies, LP includes redeem code / Ltd to 700 copies - PRAED's fourth album. This is the ultimate kit to prepare calmly for the sixth extinction! The Lebanese duo delivers a raging interpretation of the chaabi - popular Arabic music - using synthesizers, drum Machines, samples and other devices. The result is hypnotic and psychedelic, on the verge of trance. The clarinet of Paed Conca and the soaring lyricism of Raed Yassin sound like distant calls for help emerging from a world that is falling apart and slipping away. The record itself is enhanced by its sleeve - designed by the Lebanese artist Raphaëlle Macaron - printed in 5 Pantone colors making it as explosive as the music.
The Item is out of Stock. We will send You an Email as soon as it´s available again if you click on "in Stock Mail"
- A1: Doomsday Survival Kit
- B1: El Khawaga
- B2: The Spy Who Spoke Too Much
LP DELUXE EDITION includes: Pink vinyl / Poster / Redeem code, Ltd to 300 copies, LP includes redeem code / Ltd to 700 copies - PRAED's fourth album. This is the ultimate kit to prepare calmly for the sixth extinction! The Lebanese duo delivers a raging interpretation of the chaabi - popular Arabic music - using synthesizers, drum Machines, samples and other devices. The result is hypnotic and psychedelic, on the verge of trance. The clarinet of Paed Conca and the soaring lyricism of Raed Yassin sound like distant calls for help emerging from a world that is falling apart and slipping away. The record itself is enhanced by its sleeve - designed by the Lebanese artist Raphaëlle Macaron - printed in 5 Pantone colors making it as explosive as the music.
The Item is out of Stock. We will send You an Email as soon as it´s available again if you click on "in Stock Mail"
The Item is out of Stock. We will send You an Email as soon as it´s available again if you click on "in Stock Mail"
3024 is back with a quintessentially unique and current take on the hardcore continuum with a brand new Various Artists EP featuring music by label head Martyn, advanced percussive science by Yak, midsummer melancholy by Baltra and avant-techno by the Manchester/Berlin duo Juniper.
The Item is out of Stock. We will send You an Email as soon as it´s available again if you click on "in Stock Mail"
Two Thousand has always been the official symbol of the future. Two Thousand has been told, represented, drawn and played centuries before the year Two Thousand.
And now it's past."I don't wanna get rid of this: all the changes you're making now, will simply belong to Two Thousand. We belong to Two Thousand". White Label 10" w/ unknown edits that dig heavily into jazz samples but they go beyond, creating sonic impro jams including menacing low pitched arpeggios, celestial breaks of synths and far away lights of a black continent pulsating under the crisp mastering work.
Included is a nice printed poster with artwork from 2000 himself.
The Item is out of Stock. We will send You an Email as soon as it´s available again if you click on "in Stock Mail"
Dark Entries is honored to release a 4-track EP by Swiss musician Carlos Perón, founding member of Yello. Carlos was born in 1952 in Zurich and began collecting music at a young age. Inspired after attending a concert of Karlheinz Stockhausen in the 1960s, he began to compose Musique Concrete pieces using a 4-track reel to reel and found sounds. In 1979 Perón founded the trio Yello with musician Boris Blank and vocalist Dieter Meier. Yello released their first album in 1980 and the following year Carlos released his first solo album 'Impersonator'. In 1983 Carlos left Yello in order to pursue a solo career and released the soundtrack to Die Schwarze Spinne" and 1984 his second solo album Nothing Is True, Everything Is Permitted'. In 1988, Belgian label LD Records released a 4-song EP of instrumental tracks from 1984 that predated, influenced and became staples in the New Beat scene.
Dirty Songs' is a collection of songs from Carlos Perón recorded between 1980 and 1986. The recordings were made with the core set up of an ARP 2600, Roland's Drumatix, TB-303 and TR-808. Nothing Is True, Everything Is Permitted (Instrumental)' recorded in 1984 is a slow burner with dark, gloomy atmospherics, presented here in an extended version with a bonus intro. The song was inspired by William S. Borroughs' Naked Lunch' and paints a bleak futuristic landscape. Breaking In (Instrumental)', from 1984, is a crossover of electronic body music and pitched down Chicago acid house featuring overplayed snares by hand though an Ovomaltine Box. Originally featured on the soundtrack for Die Schwarze Spinne', the song is about breaking into a large pharmaceutical company to steal drugs. On the B-side is A Dirty Song (Instrumental)', originally recorded in 1986 and released by Play It Again Sam in 1988. The song uses one of the earliest Roland SH synthesizers, the SH-1 A, as a solo instrument and is strikingly aggressive with percussive rhythms. Et' was recorded in 1980 on a 4-track and later and remixed to 8-tracks in 1984 for the Frigorex' EP, which is where this extended version comes from. Featuring eerie, cut up vocals and Dadaist lyrics by Isa Nogara atop a proto-Techno beat.
All songs have been remastered for vinyl by George Horn at Fantasy Studios in Berkeley. The jacket features a never before seen black and white photo of Carlos taken in 1988. Each album includes an double-sided postcard featuring the cover art from the Frigorex' EP. Prepare to make your own movie to the Swiss John Carpenter soundtrack vibes of Carlos Perón.
Dutch label Field Records is back with another special album project, this time from Japanese producer ENA aka Yu Asaeda. Bridge is an introspective soundtrack for a documentary also called Bridge - out this Spring - which is about the Dejima bridge, a reconstructed symbol of the Dutch-Japanese trading history in Nagasaki, Japan. The album finds the producer stepping outside of his usual remit of dark ambient and experimental music, and instead comprises ten shorter tracks that touch on abstract and rhythmic sounds that define the essence of Japanese culture. Although he has worked with the director before, this is ENA's first Original Sound Track and finds him freely inspired by the movie and heading in exciting and unknown directions. Hugely atmospheric throughout, there is hypnotic repetition of sounds, strange audio design and a mixture of melancholic moods with more dreamy synths. Sometimes gloopy rhythms gently ripple beneath soothing harmonies and at others times a micro-rhythm appears through the constantly shifting and evolving found sound loops. It's a compelling and unusual album that seamlessly mixes human emotions with a mechanical sense of industry.
Dj feedback:
Mano le Tough (Permanent Vacation): "Amazing sound"
Inverted Audio: "Subconsciously affecting, emotionally invigorating work here. Loving this."
DJ Mag LA: "This album shows that the of ENA sounds are an overflowing line that perfectly combines human emotions. Feel is the perfect word to define the entire album."
Samuli Kemppi (Deep Space Helsinki): "Really really good album. Thank you."
Eric Cloutier (The Bunker NY): "absolutely brilliant."
Philip Sherburne (Pitchfork): "Really interesting stuff here, looking forward to delving into it."
Amandra (Semantica): "Love it ! Thx"
Nihad Tule (Sloboda): "perfect cinematic scapes, thanks!"
Breach (Aus Music): "super enjoyable on a lot of levels and so warm. "
Jonas Kopp (Tresor): "love it ! thanks."
Mosca (Not So Much): "First two tracks are enough for me to know I'm into this"
Fugal (BleeD): "<3"
natural/electronic.system. (Tikita): "This is a great release. Thanks!!"
Roger Gerressen (Yoyaku / Sushitech): "lovely"
Maarten Mittendorff (Indigo Aera): "Amazing all over!!! <3 ENA... really out of the box organic evolving music. Big up Field for releasing this beautifull music!"
Albert van Abbe (VANABBE / No Comment): "This is just great! Suburb travel music, thanks!"
Simo Cell (Livity Sound): "Yes this is brilliant ! "
Efdemin (Dial): "Great textures and sounds. Really interesting work!"
Clouds (Electric Deluxe): "wow this is dope!"
Zadig (Construct Re-Form): "Need to check quietly but i know i already love it. Beautiful ... Thanks !! "
Voiski (Super95): "really beautiful bridge music "
The Item is out of Stock. We will send You an Email as soon as it´s available again if you click on "in Stock Mail"
ESHU Records hits release number ten with a new EP from the in-house production collective made up of Jocelyn Abell, Ivano Tetelepta and Daniel Lekatompessy. Fraktur features six tracks of stripped back house and techno that are all atmospheric and heady. Opener Winter Track is a smooth and rolling dub techno number that is grainy and economical yet hugely absorbing thanks to its circling synth details and woody drums. Creating Moods is even more expansive and spacious, with gently swirling pads enveloping a soft, broken rubber kick drum. The title track is another expertly distilled, dry and heady groove with its frayed edges and warm analogue feel, then 'Hello' really flips the script with over driven Jeff Mills kicks and intergalactic synths bring a spooky sci-fi feel to proceedings. Yorubaland is then a cosmic ambient interlude with fax tones bleeping and blipping as lazy pads smear out in the background and last of all Core comes on strong with more quick and slick intergalactic techno carrying you off to some distant planet. This is another faultless EP from this fine Dutch collective. Pressed on 180 grams vinyl.
The Item is out of Stock. We will send You an Email as soon as it´s available again if you click on "in Stock Mail"
Ethimm's second EP When in dark delivers the groups signature tension music with moods oscillating between suicidal heartbreak and conciliatory optimism. In the opening track Why (a cover of the Rhythm and Sound classic), producer Elisabeth Thimm sets the stage for guest singer Veronique to mourn love's loss, while Brian Gimmel's improvised piano licks hold strong agains the songs relentless bassline. The follow-up track Late features Lexx's dreamy lyrics gracing a subtle dance foor tune for spaced-out souls. The B side opens with Ethimm's love for dub. Next is a freaked-out meditation on what has been and will be, while the fnal track Done slowly creeps towards its peak, refecting on dark days where light may have not been much in sight, but going forward sees optimism, increased resolution, and drive.
The Item is out of Stock. We will send You an Email as soon as it´s available again if you click on "in Stock Mail"
The Item is out of Stock. We will send You an Email as soon as it´s available again if you click on "in Stock Mail"
Boris Bunnik dons his Hexagon scuba gear before diving into electronic abstraction and aquatic electricity. Counter Utopia brings together three works of machine textures. "Cerebral Trauma" is submerged in a simmering liquor of smelted metal, molten melodies bubbling to the surface as ball bearings fizz and rattle. Industrial experimentation undercuts the entire EP. Soulful chords are stretched, contracted and contorted against the clean percussion lines of "Utopia." Machines echo in the finale. Gears groan against a backdrop of soaring synths and pulsations in the depths of "Paranormal."
The Item is out of Stock. We will send You an Email as soon as it´s available again if you click on "in Stock Mail"
There is a hidden place between science and magic. A secret playground where brainwaves rejoice and wander around. And, guess what, Modified Perspectives is all you need to reach it..
The Item is out of Stock. We will send You an Email as soon as it´s available again if you click on "in Stock Mail"
The Item is out of Stock. We will send You an Email as soon as it´s available again if you click on "in Stock Mail"
On a trip to Tokyo, steeped in thoughts about a world driven by fear, scaremongering and supremacy ever present, there was a need and desire for Rushmore to explore his own internal hope, faith and positivity - themes that lie at the core of debut album, 'Ours After'.
The LP's backbone is informed by his past musings of 90s/00s rap albums, fused with the more recent club stylings of innovative music pioneers like Spinn, Rashad (RIP) & Teklife.
At 13 tracks long, the album is a journey - and a chance for Rushmore to re-imagine the music he'd been gifted before, to become 'Ours After'.
The Item is out of Stock. We will send You an Email as soon as it´s available again if you click on "in Stock Mail"
Following on from the success of HOTPLATES001, featuring Germany's OTZ, comes the boutique Portsmouth-based label's second release - from noted Bristol producer Theo Bennett, aka Sepia.
At the forefront of dubstep's current generation of producers, Sepia has received heavyweight support from the likes of Mala, Joe Nice and Truth, with a take on the genre that ranges from moody, melodic dub-hymns through to full throttled club tracks.
The Item is out of Stock. We will send You an Email as soon as it´s available again if you click on "in Stock Mail"
- A1: Hypnotic (Feat. Shannon Saunders)
- B1: We Will Be (Feat. Matt Wills)
- B2: Wash Away
- C1: Sweet Lies (Feat. Karen Harding)
- C2: Breathe (Feat. Shannon Saunders)
- D1: Take Me Home (Feat. Andreya Triana)
- D2: Brand New
- E1: Only The Innocent (Feat. Raphaella)
- E2: In The Dark (Feat. Livvi Franc)
- F1: Heaven (Feat. Shannon Saunders)
- F2: Let You Know
- G1: Run (Feat. Jem Cooke)
- H1: Flatline (Feat. Wretch 32)
- H2: Faded (Feat. Negin Djafari)
Wilkinson smashes down the barriers of Drum'n'Bass with 'Hypnotic', fusing the genre he grew up listening to with pop sensibilities that appeal to a global audience, whilst experimenting with different tempos and genres. Always keen to champion new rising talent, Wilkinson has teamed up with some of dance music's rising stars including Shannon Saunders, Matt Wills and Karen Harding and established talent in the form of Wretch 32. Hailed as one of the brightest stars in dance music, 'Hypnotic' follows Wilkinson's debut album Lazers Not Included.
LP price is due to it being a 4 piece vinyl in slip case box. limited to 1000 copies
The Item is out of Stock. We will send You an Email as soon as it´s available again if you click on "in Stock Mail"
The King is a remarkably absorbing collection of abstract torch songs by Cee Haines aka Chaines, a Manchester-based artist in possession of a starkly singular sonic language, who has collaborated extensively with the London Contemporary Orchestra and had their work performed at The Roundhouse, Union Chapel, Printworks and Tate Modern.
Leading a thematic expansion of Chaines' OST (2015), their 2nd solo release yields a phantasmic and richly evocative soundtrack-esque series of works written over the past three years, including exclusive versions of their commissions by the LCO and Union Chapel, all serving to frame an intimate yet beautifully elusive portrait of a unique artist coming into their own.
In eight parts, Chaines draws a mercurial line that connects the almost bestial intimacy of purring strings and whispered vocals in For Your Own Good to something like Scott Walker-invoking-
Fantasia in Eraserhead, conjuring a mutably surreal and mystic atmosphere that keeps listeners teetering between knife-edge suspense and sublime relief as they scale from delectably detailed
avant-garde psychedelia in Knockturning to a bout of Grouper-as-spectral-Jazz diva styles of Population 5120, and all in a way that makes the exploded hyaline castles in the sky dimensions of Airship seem totally feasible next to the cavernous avant-techno impulses of Carpathia. Never following a linear path, Chaines is as likely to incorporate doom-laced chamber motifs and
asymmetric techno rhythms as operatic vocals and microscopic sounds, always with a sensitivity to the metaphysics of space and spirit which coolly sets their work apart.
Held up beside Slip's celebrated recent releases such as Yeah You's Krutch and Object Collection's opera-in-suspension based on Fugazi, It's All True, Chaines find themselves amid exemplary,
boundary-morphing company, whose diversity finds a common strength in the will to express something of a pathos beyond easy comprehension, yet which can be felt and understood
immediately and instinctively by anyone with an open mind and a thirst for the new.
The Item is out of Stock. We will send You an Email as soon as it´s available again if you click on "in Stock Mail"
Chase & Status release their next two-track bundle from the RETRUN II JUNGLE project, featuring dancehall legends Burro Banton and Mr. Vegas.
RETURN II JUNGLE IS cultural movement - inspired by British music and fashion of the golden years of Jungle music from the mid-late 90's. The sound, project and accompanying documentary and installation, will draw on Jungle music whilst also transporting it into the present day, and re-vamping the genre for the modern day music fan. 'We will be representing DnB at it's most soulful, raw, and uncut level' (Will Kennard)
The Item is out of Stock. We will send You an Email as soon as it´s available again if you click on "in Stock Mail"
Zoom is a verité collection of situational recordings made by Cucina Povera - aka Finnish-born, Glasgow-based sound artist Maria Rossi - in intimate spaces full of acoustic or ideological intrigue, primarily using a capella voice. It is a document of different locations and moods that interested the recorder, a postcard look into the stream-of-consciousness processes of an artist developing her own language. Using little else other than a Tascam Zoom recorder and loop pedal these are highly personal recordings originally intended as notes for future compositions that ended up becoming the purest rendition of this first phase of Cucina Povera's music to date.
Originally presented as WAV files named simply ZOOM---, these on-the-fly compositions are a perfect distillation of Rossi's practice. With no augmentation, not even a song-title, these bare, beautiful tracks become a materialist document of the wonder of the every-day. While Rossi's previous album, Hilja, was a sculpted whole that at times used post-production techniques and electronic instruments, Zoom presents acoustic sound as a source of joy and discovery largely without artifice. Rossi's voice is used a searchlight, shining into the crevices of a room's dark corners, or as on ZOOM0005, projected into a Coke bottle aperature, for an almost Shakutchi texture. Voice's meaning dissapates into texture, with rhythms created by simple hissing sounds and the interweaving of loops. ZOOM0001 interlocks 4 different a capella melodies to create a chorus, an improvised solo hymn that seems to rise and rise. ZOOM0010 uses staccato vocal bursts, like Meridith Monk huffing out Steve Reich rhythms, while the soloing Rossi expertly ducks in and out of the frame. Like the most celestial moments of her debut Hilja it is a religious experience but rendered more powerful in its naked form.
Indeed, there are shades of Hilja in the sounds, with some strains resurfacing from that album, insinuating that Rossi's practise is a continuing form, a series of sentences in the artists' personal language that mutate over form, bending into new shapes. On Zoom, Rossi's minimalism is fully stark, a process fully transparent and all the more celestially powerful because of it.
The Item is out of Stock. We will send You an Email as soon as it´s available again if you click on "in Stock Mail"
Perhaps one of the most unique and unlikely exponents of the highly collectible genres of ambient electronics, experimental tape-music and PINA (Private Issue New Age), this English-born Jamaican- raised sound designer, artist and existentialist furrowed his own unblinkered path through lesser chartered electronic fields for many moons before eventually teaming up with Bill Laswell (with Material) and Daevid Allen in New York to bring self-taught synthesis to Gong during their most oblique periods.
Creating two impossibly rare self-pressed vinyl LPs of conceptual inner-visionary outer-galactic angular tonal-dronal alien-art soundscapes in the process, the man known under figure shifting guises such as Dennis Wise/Denis Weise/Dr. Wise etc, combined a culture of sound system circuitry and radiophonic trickery adding Tea-pot poetry and sci-fidelity future- folk to his magnetic mesh.
Presented here as the first ever dedicated Wize Music collection this record combines compositions spanning 1979-1984 in both a solo capacity as well as small- group projects featuring members of the Emerald Web band.
Imagine a comic book where a Funkenstein monster called 'Laraaji-Scratch Perry' invaded your record shelf while Komendarek and Holger Czukay kept lookout... Dr. Dennis might be the only one Wise enough to outsmart all of them with his powerful amorphous anaesthetic.
A killer blast of Linekraft's Japanese junk metal cut-ups and cyclonic noise, new on Hospital Productions.
Japan's foremost exponent of 'metal junk' cut-ups transposes the nihilist energy of his notorious live shows into this devastating debut LP for Hospital Productions. Hailed by Prurient's label as 'the premier industrial performance unit arising from today's contemporary Japanese underworld',
Masahiko Okubo a.k.a. Linekraft lives up to this mantle with a severely brutal suite of hacked and charred concrète noise.
Like his predecessor Kimihide Kusafuka's K2 ventures in the same arena (we imagine a cage, a bit like Robot Wars or MMA), Linekraft rudely manhandles his recordings of percussion and
vocals, pitching them into a morphing torrent of abusive clangour and analogue chicanery with Kafkaesque results.
The Item is out of Stock. We will send You an Email as soon as it´s available again if you click on "in Stock Mail"
IDA007 is a vinyl release entitled 'Pagan Rave EP' by label's co-founders Uninc & Kolomensky coming up from the emerging Moscow scene.
Title track opens EP with breakbeat groove, flute solos and slavic vocals combined with progressive and acid lines to deliver unexpected mix of pagan folk music and rave rhythms.
'Ancient Tool' is another original track on the A-side with tribe vocal samples combined with acid and punchy rhythm section filled up with bongos to create a dancefloor oriented DJ tool with ancient flavor.
On the remix duties at the B-side are Ransom Note's craftsman Timothy Clerkin with slow atmospheric and meditative version of 'Pagan Rave' and quickly emerging Olsvangèr from Tel-Aviv who delivers weird oriental progressive club banger made up from the 'Ancient Tool'. Overall there is an 12'' saturated with different vibes neatly crafted and mixed together for a wide range of feelings for the listener and tools for the DJ.
Welcome to a time of global sousvelliance and psychophysical burnout _
Welcome to an inconsistent present that calls for schizophrenic rhythms and mutable harmonies _
Welcome to a future that doesn't need you anymore _
Welcome to your world _
Welcome to End2End _
The Item is out of Stock. We will send You an Email as soon as it´s available again if you click on "in Stock Mail"
2x12"
An artist as versatile as Alex Krüger is a rare find these days, not only did he release numerous EP's and albums as Tigerskin or Korsakow since the mid 90s, he's also been on the forefront of the 'Dub Techno' movement since 1999 with outings on classic labels such as 'Raum...Musik", 'Force Tracks' and '3B/ United States of Mars". Now ten years after his last album on 'Opossum Recordings' Alex is back with this well crafted genre bending full length 'Caves & Cages". From deep techno cuts through rippling ambient excursions to funky reggae infused live jams with Haushausen this work is yet another milestone in the creative bubble Alex lives in (i.e. his studio). A predominantly analogue producer, Alex recorded most sounds for 'Caves & Cages' on his modular synths and vintage gear at Organic Domain during 2017 and early 2018. Throughout the album tension ebbs and flows effortlessly via syncopated subs, analogue improvisation, subtle chord stabs and sustained swells interspersed with textured field and home recordings. The ambient opener 'Intra' sets the tone for the album. Rich with alien atmospheres, distant soundscapes, out of reach voices and licks of live instruments dug up from numerous recordings dating back as far as 30 years, even before Alex started his electronic journey. The sojourn ventures deeper from there. Subaquatic dub techno is the mood on 'King's Cave", 'Helix' and 'In Air' only surfacing ever so slightly for moments of clarity where shimmering tops and glistening synth lines shed some light on the steady grooves. The tracks 'Future History' and 'Transition State CIV' border on deep house territory.
The Item is out of Stock. We will send You an Email as soon as it´s available again if you click on "in Stock Mail"
Electro-Psych Origins! Nobody went full-on electro-rock before Fifty Foot Hose. Before their brief-but-groundbreaking run in the late '60s, Bad Trips collects the demos, outtakes, and other rarities that complete the story of a band too far ahead of its time to last. From the pre-Hose tracks of boldly atonal, proto-psychedelic freakout music to early versions of songs that would land on their opus, Bad Trips boldy displays how Fifty Foot Hose changed the landscape of rock and experimental electronic music.
The Item is out of Stock. We will send You an Email as soon as it´s available again if you click on "in Stock Mail"
Subliminale Materiale is the 5th installation on Lustpoderosa. Kind of a split EP. The A side with two remixes and two original jams of Jack Pattern on the B side. With this release we want to point out the remixes on the A side. Both done by Lustpoderosas favourite producers and DJs: Sneaker aka Dunkeltier (Uncanny Valley, Rat Life, Frigio) and Kris Baha (Power Station, Pinkman Cocktail D`Amore) . We guess you know and love them as much as we do.
On own imprint Jimi Tenor releases a 4 track 7" for Kati Juurus' film Cinema Dadaab. While in the field of Jazz-Funk it has a pinch of avant garde, and more than a little touch & texture of the Middl East. Resembling stady late 60 jazz, but melodically travelling towards psychedelica and most of all eastern tonalities it's a combination of traditional, crafted and compact story telling.
The Item is out of Stock. We will send You an Email as soon as it´s available again if you click on "in Stock Mail"
...it must affect the brain in some way, unless it's just the music that does it All them lights flashing don't do you any good either...
Recorded in Curve Pusher's former Hackney premises over a series of sessions during 2016-2017, L-R is the name for the sounds that have emerged from the collaboration of friends Simon Lynch (London Modular Alliance), Monoak (Freerotation) and Radioactive Man. Oscillating modular sequences from the units Simon brought to sessions, multi-MPC powered beat programming, and TB 303 patterns being fed to a MiniMoog is the backbone of this record, some of the last sessions at Curvepusher studio, London, before its move to Hastings. Where we get the best out of these three singular producers.
Asking for Trouble is Keith Tenniswood (Radioactive Man's) record label - established in 2017 to home his solo and collaborative studio work.
The Item is out of Stock. We will send You an Email as soon as it´s available again if you click on "in Stock Mail"
ORACULO RECORDS is proud to be again the selected label for another very awaited album advance. In this case, NEON ELECTRONICS 'Apollo', to be released in early 2019. Leadered by Dirk Da Davo (Ex The Neon Judgement), NEON ELECTRONICS plays on the bounds or krautdarkrock and minimalistic ebm pushing the audience to a lysergic trip. This EP includes as well an amazing live version of TNJ super classic 'TV Treated' recorded in 2018. It will be presented on 12 EP format and produced in a ONE-OFF truly limited edition of 300 copies lacquered pressed on 180 gr. high quality solid black vinyl. All tracks have been specially mastered and remastered for LONG CUT vinyl by Eric Van Wonterghem.
Shakarchi & Stranéus inhabit a secret place in the universe of music, one existing at the intersection of Scandinavian poplands, Hisingen forest raves and outernational placelessness. Faik Shakarchi and Daniel Stranéus famously started making beats together in the Gothenburg tapas-joint coat check where they both worked as clerks. Their now 10 years old friendship is the story of legends, their sparse vinyl output the secret love of deep house 12'' enthusiasts round the globe - the warm, vibrant sounds found on those records a stark contrast to the stripped-down effectiveness of their marathon DJ sets, frequently heard within the more nefarious examples of GBG nightlife. The duo has also been a part of Studio Barnhus since the very beginning, first letting us into their strange and cozy world with the Dödskallar och korallrev EP in 2010, effectively turning what was then a one-release operation into a Record Label. The distinctive sound of that early material (described by one Discogs commenter as enlightened, naive future dub for children') has been expanded upon and further defined on their debut album Steal Chickens from Men and the Future from God, its 12 cuts lovingly selected from a plethora of works floating in and out of makeshift studios from Storgatan to Gamlestan over the last 7 years. The record took its final form at Nacksving, same place where recent albums from Talaboman and Kornél Kovács were sonically perfected in cahoots with mix engineer Matt Karmil. Steal Chickens from Men and the Future from God is released on all digital platforms, as CD and as DJ friendly double vinyl on March 23rd 2018.
The Item is out of Stock. We will send You an Email as soon as it´s available again if you click on "in Stock Mail"
First of the year on Butter Sessions sees label heads Sleep D return with their first solo EP since 2017. Two unclassifiable, deep and euphoric bangers come out of the woods with elements of techno, idm and bass music.
Opening up the record we have 'U+Zone' a sweet and heart warming electro-cosmic force that takes inspiration from the deep ocean and the stark, spacious landscape of outback Australia.
Emerging on the flip, 'Centro' turns the mood to the darker side with it's eerie chords and choir harmonies, held together with a monstrous drum and bass rytm designed for the freaks and geeks out there.
Pressed at 45rpm for extra fatness.
The Item is out of Stock. We will send You an Email as soon as it´s available again if you click on "in Stock Mail"
Sydney Valette has earned a solid reputation among post-punk scene of Paris. 'Space and Time' is a sample of his very upcoming new album. Minimal synthetic maneuvers combined with sharp guitars for a perfect modern dark sound, probably his best studio work to date. It arrives presented on 12 EP format and produced in a ONE-OFF truly limited edition of 300 copies lacquered pressed on 180 gr. high quality solid WHITE vinyl. All tracks have been specially remastered for LONG CUT vinyl by Eric Van Wonterghem.
The Item is out of Stock. We will send You an Email as soon as it´s available again if you click on "in Stock Mail"
- A1: John Holt - Police In Helicopter (Benny L Remix)
- A2: Degs - Poveglia (Feat. De:tune) (Whiney Remix)
- A3: Fred V - Burning Me
- B1: London Elektricity - Funkopolis
- B2: Flava D - Return To Me
- B3: Inja X Whiney - Be My Cure
- B4: Krakota - Reload
- C1: Bou X Unglued - Ascendant Man
- C2: S.p.y - Dusty Fingers (Feat. Diane Charlemagne) (Metrik Remix)
- C3: Mrsa - Nail Out
- D1: Lakeway - War Dub
- D2: Grafix - Frozen
- D3: Logistics - Levitate
- E1: Mitekiss - Lie Awake (Feat. Degs)
- E2: Makoto X Hugh Hardie - Bluebird
- E3: Gridlok - It's Not Techno
- F1: Anile - Allergens (Bop Remix)
- F2: Impish - Hive
- F3: Polaris - Alignment
- G1: Pete Cannon - Ella
- G2: Murdock - Headshot
- G3: In:most X Saikon - Untold History
- H1: Zephire - Desperation (Primate Remix)
- H2: Dip Vertigo & Dr. Apollo - Red (Feat. Josh Phillips)
- H3: Walk:r - Solis
Hospital Records proudly present the next chapter in their massive compilation series, 'Sick Music 2019'. It's packed with 25 brand new and
exclusive tracks from Hospital and Med School surgeons alongside some very special guest features, all carefully selected as the future drum & bass
anthems of 2019. This diverse selection of 174 beats comes from the likes of London Elektricity, Fred V, S.P.Y, Metrik, Grafix, Logistics, Whiney, Unglued, Benny L, Flava D, Bou, Pete
Cannon, Gridlok and many more. After the announcement of the dynamic duo's decision to focus on individual
projects, Fred V and Grafix present their first solo releases in almost a decade. Renowned for synth-driven symphonies and soothing songwriting, Fred V brings
a high dose of octane electronica in the down tempo fix, 'Burning Me'. Grafix has taken a fresh direction with 'Frozen' travelling down the rough and rugged techy
route, ready to shatter dancefloors worldwide. Plus it's about to be a big year for Hospital Records' commander-in-chief London Elektricity as he returns from the
studio a the dynamic funk-ladened D+B spectacular, 'Funkopolis'. Other highlights include Benny L's re-rub of John Holt's reggae hit 'Police In
Helicopter', with a rugged bass to make the rave shake. The first lady of Bassline and UKG royalty Flava D also joins the fold for an exclusive first flex into the realms
of D+B, the silky slick selection 'Return 2 Me'. The latest rendition of our 'Sick Music' series also sees a string of all-star remixes with Whiney's robust rework of
Degs' summer anthem 'Poveglia', Bop's long awaited glitch-riddled remix of Anile's 'Allergens' and S.P.Y's 'Dusty Fingers' getting a special Metrik rework.
The Item is out of Stock. We will send You an Email as soon as it´s available again if you click on "in Stock Mail"
- A1: Swords
- A2: Avalanche
- A3: Vessel
- A4: Hikikomori
- A5: Ixode
- A6: Seekir
- B1: In Your Nature
- B2: Lick The Palm Of The Burning Handshake
- B3: Shivers
- B4: Skin
- B5: Collapse
In the last three years Nika Roza Danilova has gone from being an outsider, experimental, teenage noise-maker to a fully-fledged, internationally-celebrated, electronic-pop musician. It was a huge accomplishment, and, despite her age (young), her origins (mid-western, desolate), her accelerated scholastic achievements (high school and college were each completed in three years) and her diminutive physical size (4'11', 90 lbs), she has triumphed. She has emerged as a figurehead— a self-produced, self-designed, self-taught independent woman. Zola Jesus is not a singer, she is a musician. Zola Jesus is not a band, it is a solo project. That is not to say the people who have helped her along the way were not deeply important. Her irreplaceable live band (whose drummer Nick Johnson lends a hand on several tracks here) and her friend Brian Foote (who co-produced this album), in addition to the live string players who contribute here (Sean McCann, Ryan York), were all crucial in the process. Still, Nika is a woman who can command a room—any room—without needing a band, a stage, or even a microphone. Her voice is unmistakable; it cuts right to the core. Conatus is a huge leap forward in production, instrumentation and song structure. The definition of the title says it all: the will to keep on, to move forward. From thumping ballads to electronic glitch, no sound goes unexplored on her new record. It is an icy exploration in refined chaos and controlled madness, an effort to break through capability and access a sonic world that crumbles.
The Item is out of Stock. We will send You an Email as soon as it´s available again if you click on "in Stock Mail"
The Item is out of Stock. We will send You an Email as soon as it´s available again if you click on "in Stock Mail"
Next up on the ever-eclectic XVI Records, a shadowy figure steps into the spotlight: enter the mysterious Captain Over, whose dark yet soulful bruk-infused tracks soundtrack the next stage of their voyage towards the sun. For his debut outing, Captain Over calls on the abstract vocal stylings of the legendary Trim (Roll Deep, 1800 Dinosaur) on opening track 'SICK'.
Showcasing why he's one of the most iconic and forward-thinking MC's to grace the mic, Trim's dulcet tones twist through a jungle of shuffled beats and subterranean sub-bass, an eerie child-like melody drifting overhead.
Clack Clack and No One Ever Really Flies inhabit a more dancefloor friendly space, their unique syncopation, fierce instrumentation and relentless energy open up the dancefloor for some real get loose moments.
On the remix, they hand the controls over to XVI homestay Books (following on from the success of his previous 'Feel It In My Bones' and 'High Praise Edits Vol 1' releases which won praise from the likes of The Black Madonna, Moodymann, Gilles Peterson and Seven Davis Jr) Books expertly crafts a cosmic footwork jam, full of his trademark soulful chords and eerie midnight saxophone licks.
As he prepares to launch his forthcoming EP 'No-One Every Really Flies' into the cosmos ; Captain Over is beginning to cement his place as one to watch in the UK underground - a sequel EP featuring grime upstart Nico Lindsay is scheduled for release later in the year, with several more collaborative works in progress.
+++